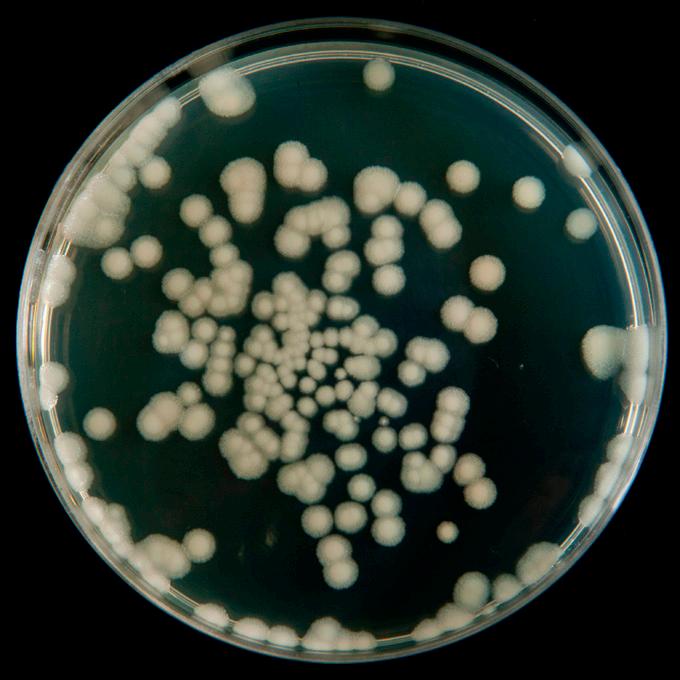

Los alimentos renderizados son harinas de subproductos cárnicos de alta calidad que aportan nutrición, mejora la formulación en la alimentacion de peces y camarones y suma puntos a tu huella ambiental.



![]()


Los alimentos renderizados son harinas de subproductos cárnicos de alta calidad que aportan nutrición, mejora la formulación en la alimentacion de peces y camarones y suma puntos a tu huella ambiental.











• Nutrición consistente y confiable
• Mayor biodisponibilidad de lípidos
• Probióticos dirigidos para la reducción de vibrio
• Vpak para la mejora del sistema inmunológico





Secciones fijas
Noticias de la industria
Investigación y desarrollo
Caracterización de la biosíntesis de nanopartículas de oro (Np-Au) con el biorreductor Chaetoceros calcitrans como potencial inhibidor de la enfermedad de AHPND en Litopenaeus vannamei
Sanidad Acuícola
Acuicultura de tilapias, enfermedades emergentes y papel de los microbiomas cutáneos en la salud y la enfermedad
Directorio
In Memoriam
Humberto Villarreal Colmenares
DIRECTOR Salvador Meza info@dpinternationalinc.com
EDITOR ASOCIADO Marco Linné Unzueta
COORDINADORA EDITORIAL Karelys Osta edicion@dpinternationalinc.com
DIRECCIÓN ADMINISTRATIVA Adriana Zayas Amezcua administracion@dpinternationalinc.com
COLABORADORES EDITORIALES Carlos Rangel Dávalos
DISEÑO EDITORIAL / PUBLICITARIO Perla Neri / Rozana Bentos design@dpinternationalinc.com
VENTAS Y MARKETING crm@dpinternationalinc.com
CIRCULACIÓN Y SUSCRIPCIONES Renée Meza suscripciones@panoramaacuicola.com
OFICINA EN LATINOAMÉRICA
Empresarios No. #135 No. Int. Piso 7 Oficina 723, Col. Puerta de Hierro, C.P. 45116 Zapopan, Jal., México. Cruza con las calles Av. Paseo Royal Country y Blvrd. Puerta de Hierro
Tels: +(33) 8000 0578
OFICINA EN ESTADOS UNIDOS DP INTERNATIONAL INC. 401 E Sonterra Blvd. Sté. 375 San Antonio, TX. 78258 info@dpintertnatinonalinc.com
COSTO DE SUSCRIPCIÓN ANUAL $750.00 M.N. DENTRO DE MÉXICO USD $100.00 EE.UU., CENTRO Y SUDAMÉRICA €80 EUROPA Y RESTO DEL MUNDO (SEIS NÚMEROS POR UN AÑO)
PANORAMA ACUÍCOLA MAGAZINE, Año 30, No. 5, julio - agosto 2025, es una publicación bimestral editada y distribuída por Design Publications, S.A. de C.V. Av. Empresarios #135 Piso 07 Oficina 723 Col. Puerta de Hierro CP. 45116. Zapopan, Jalisco, México. Tel: +52 (33) 80 00 05 78, www.panoramaacuicola.com, info@dpinternationalinc.com. Editor
Responsable: Salvador Antonio Meza García. Número de Reserva de Derechos de Uso Exclusivo 04-2019071712292400-01, licitud de Título No. 12732, Licitud de Contenido No. 10304, ambos otorgados por la Comisión Calificadora de Publicaciones y Revistas Ilustradas de la Secretaría de Gobernación. Permiso SEPOMEX No. PP-14-0033. Impresa por Negocios Gráficos Grafinpren S.A. Teléfono: 04-2221362 ext 28 / 0959537917. Av. C.J. Arosemena Km 2.5 Antiguo Coliseo Granasa, Guayaquil, Ecuador. Este número se terminó de imprimir el 31 de julio de 2025 con un tiraje de 3,000 ejemplares.
La información, opinión y análisis contenidos en esta publicación son responsabilidad de los autores y no reflejan necesariamente el criterio de esta editorial. Queda estrictamente prohibida la reproducción total o parcial de los contenidos e imágenes de la publicación sin previa autorización de Design Publications, S.A. de C.V.
Tiraje y distribución certificados por Lloyd International
Visite nuestra página web: www.panoramaacuicola.com

También síganos en:
Artículo
PromegaBiotic-f® OM
La solución definitiva para eliminar la materia orgánica en cultivos acuícolas
Artículo
La harina de subproductos avícolas en las dietas de salmón del Atlántico cultivado contribuye a un alto rendimiento en el crecimiento, al bienestar de los peces y a la calidad del filete en condiciones de campo similares a las comerciales
Artículo
Para el intestino: el control de Vibrio se mejora con probióticos microencapsulados
Artículo
Innovación y ciencia aplicada para una fase de agua dulce más eficiente y sostenible
Artículo
Abordando los desafíos de salud del camarón a través de la nutrición funcional
Artículo
Aditivos microbianos:
Una seguridad frente a los desafíos diarios
Artículo
Entendiendo el uso de probióticos biorremediadores del género
Bacillus en acuicultura
Artículo
DIGEXTRA AQUA
Evaluación científica de un aditivo funcional de nueva generación en la tilapicultura latinoamericana
Artículo
De los sonidos de los camarones al ahorro: cómo ShrimpTalk de Eruvaka optimiza la eficiencia de la alimentación
Artículo
Lima se prepara:
Empieza la cuenta regresiva para la apertura de Expo Pesca & Acuiperu - Seafood Lima 2025










Carpe Diem
En la mira
Financiamiento para la acuicultura
Nueva era en tecnologías acuícolas
Cómo sobrevivir en la época de “influencers” y “excelsheeters”
¿Pueden los probióticos para camarones prevenir o curar enfermedades?
Crece el consumo de seafood en México por el boom turístico y otros aspectos
La acuicultura: del idealismo a la realidad empresarial
Fermentación aplicada a la acuicultura: innovación con subproductos agrícolas para mejorar la calidad del agua y la sanidad animal

En la actualidad, hablar de Inteligencia Artificial (IA), es hablar de la capacidad de las máquinas para simular la inteligencia humana y realizar tareas que normalmente requieren habilidades cognitivas humanas, como el aprendizaje, la comprensión del lenguaje y la resolución de problemas en una amplia variedad de campos. La IA abarca desde asistentes virtuales y vehículos autónomos hasta la realización de diagnósticos médicos y análisis de datos empresariales. Esto se logra a través del análisis de grandes volúmenes de datos (big data), lo que permite identificar patrones y tendencias y, en consecuencia, formular predicciones de manera automática con rapidez y precisión.
Si bien la IA proporciona herramientas para responder preguntas, realizar tareas y controlar dispositivos en la automatización de procesos, lo que permite ahorrar tiempo y recursos, y tomar decisiones más rápidas y basadas en información más precisa, esto depende del entrenamiento de las máquinas para que reconozcan patrones en los datos y tomen decisiones en función de ellos.
Sin embargo, la acuicultura se encuentra inmersa en sistemas altamente cambiantes. A pesar de la intervención humana para criar y gestionar los organismos acuáticos en un entorno controlado, se enfrenta a grandes desafíos como la gestión del agua, la prevención de enfermedades y el impacto ambiental.
De acuerdo con la FAO, el análisis de los factores que afectan al desarrollo de la acuicultura y su aplicación para pronosticar la producción, ha permitido identificar cinco factores clave: ambiente, espacio, tecnología, producción y mercadeo. Si bien estos factores pueden estandarizarse para su incorporación a la IA, se requiere información específica que permita la adaptación, no la “clonación”, de las herramientas de toma de decisiones. Esto se debe a que cada factor establece condiciones particulares:
1. Ambiente: idoneidad de las áreas geográficas para el desarrollo de la acuicultura, incluyendo temperatura, precipitaciones, insolación, calidad y cantidad del agua, entre otros.
2. Espacio: consideración de la competencia entre distintos grupos de usuarios por zonas de interés, como zonas costeras residenciales o recreativas, así como tierras agrícolas y explotadas.
3. Tecnología: disponibilidad local de información adecuada sobre la tecnología relativa al cultivo y a los productos, que proporcione una base tecnológica sólida para el desarrollo de la acuicultura. Esto incluye servicios de difusión de información, capacitación y extensión.
4. Producción: disponibilidad de personal con conocimientos técnicos y administrativos, o de medios de formación, en el área en cuestión.
5. Mercadeo: abarca elaboración, conservación y envasado de los productos acuícolas, su transporte a los centros de población y su venta a distribuidores, mayoristas, minoristas o consumidores.
Como se puede observar, todos los factores mencionados, excepto el ambiente físico, representan condiciones que el ser humano, con su actividad, puede modificar en mayor o menor medida. Incluso el ambiente físico hará impracticable técnicamente la acuicultura solo en áreas en extremo desfavorables. Sin embargo, ambientes físicos moderadamente desfavorables pueden hacer que la acuicultura resulte antieconómica, ya que puede ser preciso establecer hábitats controlados, con altos costos, para obtener condiciones ambientales adecuadas para el crecimiento de las especies seleccionadas.
Por lo anterior, es imprescindible hoy en día el uso de la IA. No obstante, el factor humano es necesario para la incorporación de información que permita a la tecnología realizar tareas y controlar dispositivos en la automatización de procesos. Es de vital importancia la información adquirida en el día a día por técnicos, operarios y, sobre todo, tomadores de decisiones, para que se establezcan los mejores protocolos de producción acuícola.
21/08/1960 21/07/2025
Con profundo pesar comunicamos el fallecimiento del Biol. Julio Figueroa López, un pilar de la acuicultura en México.
A lo largo de su destacada trayectoria, dedicó su vida al desarrollo técnico y sostenible del cultivo de ostiones y camarones, aportando conocimiento, pasión y compromiso al crecimiento del sector. Fue cofundador de la revista Panorama Acuícola Magazine, medio que se ha convertido en una referencia clave para la industria acuícola de habla hispana. Su visión editorial y su compromiso con la difusión científica ayudaron a fortalecer la comunicación técnica dentro del gremio.

Julio fue más que un profesional brillante; fue un colega generoso, un formador incansable y un amigo leal, siempre dispuesto a dar una mano. Su trabajo contribuyó significativamente a proyectos que hoy son ejemplo, y su legado seguirá vivo en las generaciones que inspiró y en las prácticas que ayudó a transformar.
Acompañamos a su familia, amigos y colegas en este momento de dolor, con gratitud por todo lo que compartió en vida.
Descanse en paz.

La producción de camarones en Indonesia se encuentra entre las mayores del mundo, la cual se ha visto afectada por la enfermedad de necrosis hepatopancreática aguda (AHPND, por sus siglas en inglés). Este artículo resume los resultados de una investigación cuyo objetivo es determinar la biofabricación, caracterización y eficacia de nanopartículas de oro mediada por Chaetoceros calcitrans como antibacteriano contra AHPND en camarón blanco del Pacífico.
Por: Redacción de PAM*
Introducción
Indonesia es el tercer exportador mundial de camarones, después de Ecuador y la India. La producción de camarones aumentó un 21%, de 1.21 millones de toneladas a 1.48 millones de toneladas en 2021-2022, pero disminuyó a 1.097 millones de toneladas en 2023 (KKP, 2023). Sin embargo, uno de los obstáculos que
siguen enfrentando los acuicultores son las enfermedades. La enfermedad de la necrosis hepatopancreática aguda (AHPND, por sus siglas en inglés) es una de las causas del descenso de la producción, porque provoca la muerte del 100% de los camarones vannamei y solo hasta un 35% de los acuicultores son capaces de completar un ciclo de
cultivo con una supervivencia del 50% de la población. Por lo tanto, es necesario innovar en el manejo del AHPND para evitar mayores pérdidas, considerando que el camarón blanco del Pacífico (Litopenaeus vannamei) es uno de los principales productos de exportación.
La AHPND es causada por Vibrio parahaemolyticus, que tiene un

Es necesario innovar en el manejo del AHPND para evitar mayores pérdidas, considerando que el camarón blanco del Pacífico (Litopenaeus vannamei) es uno de los principales productos de exportación.

plásmido virulento único, el cual contiene el gen de la toxina Pir. La toxina Pir consiste en ToxA y ToxB codificadas por los genes Pir-A y Pir-B. Esta toxina forma un complejo heterodimérico que se une a los receptores en el hepatopáncreas del camarón, causando necrosis aguda. La AHPND en el L. vannamei se trata con sifonado y antibióticos. El sifonado no es eficaz para reducir los niveles de amoníaco en el agua, por lo que los camarones experimentan estrés y se inhibe su crecimiento; mientras que altas dosis de antibióticos causan resistencia bacteriana y dejan residuos. Rezaee et al. (2020) demostraron que los bacteriófagos pueden inhibir la bacteria V. parahaemolyticus, pero también causar resistencia a las bacterias patógenas. Solo Sun et al. (2023) reportaron que las nanopartículas de oro (Np-Au) pueden detectar V. parahaemolyticus en el camarón blanco del Pacífico, no así como agentes antimicrobianos.
Las Np-Au son un tipo de nanopartículas metálicas usadas como portadoras y estabilizadoras de fármacos. Las nanopartículas metálicas tienen un mecanismo de toxicidad inespecífico único, a la que las bacterias no son resistentes (Hassan et al., 2023). Sin embargo, su toxicidad es elevada en los organismos objetivo y en el medio ambiente. El método de biosíntesis de nanopartículas metálicas con plantas herbáceas, fitoplancton y poliquetos puede reducir su toxicidad. Los metabolitos secundarios en materiales naturales como: aminoácidos, ácido cítrico, terpenoides, polifenoles y polioles pueden funcionar como agentes reductores, así como agentes de recubrimiento (estabilizadores) para nanopartículas de iones metálicos (Pal et al., 2019; Wang et al., 2019). Este método es superior porque es respetuoso con el medio ambiente, eficiente energéticamente (temperatura ambiente) y con un uso mínimo
de productos químicos. Hassan et al. (2023) investigaron más a fondo las Np-Au con Marphysa morbidi (polychaeta) como antibacteriano para la AHPND. El contenido bioactivo de fenoles, ésteres y ácidos grasos en M. morbidi puede reducir la toxicidad y estabilizar los iones metálicos Au3+ en nanopartículas Au0. Sin embargo, la extracción de principios activos en M. morbidi se considera subóptima debido a los disolventes menos polares y orgánicos y la dificultad de su obtención, porque se encuentra en la costa de Malasia, por lo que es necesario disponer de un M. morbidi alternativo como reductor y estabilizador de Np-Au.
Chaetoceros calcitrans es una especie universal de la clase Bacillariophyceae y se encuentra ampliamente en la costa de Pamekasan, Java Oriental, con una densidad de entre 700 y 9,100 ind/L en julio - agosto (Indriyawati et al., 2023). Contiene muchos metabolitos
La AHPND es causada por Vibrio parahaemolyticus, que tiene un plásmido virulento único, el cual contiene el gen de la toxina Pir. La toxina Pir consiste en ToxA y ToxB codificadas por los genes Pir-A y Pir-B. Esta toxina forma un complejo heterodimérico que se une a los receptores en el hepatopáncreas del camarón, causando necrosis aguda.
secundarios: terpenoides, flavonoides, taninos y esteroides que pueden inhibir las bacterias patógenas. Soto-Rodríguez et al. (2021) reportaron que los compuestos hidrofílicos de las células de C. calcitrans poseen actividad antibiótica contra V. parahaemolyticus M0904, una cepa responsable de la AHPND. Sin embargo, su actividad antibiótica es todavía baja por lo que necesita ser optimizada. La extracción óptima de poliquetos se realiza con metanol, el cual es tóxico, razón por la que se requieren alternativas similares como el etanol que son más seguras. En resumen, los metabolitos secundarios de C. calcitrans tienen un gran potencial como agentes reductores y estabilizadores de Np-Au, a través de métodos de biosíntesis, para producir antibacterianos AHPND efectivos a bajas dosis que no causen resistencia bacteriana ni residuos, y puedan usarse a largo plazo.
Metodología de la investigación
La investigación experimental se llevó a cabo durante cuatro meses (mayo - agosto), en la cual se emplearon: C. calcitrans, etanol al 96%, HAuCl4 3H2O 1 mM, V. parahaemolyticus aislado en 108 UFC/ ml (estándar de 0.5 McFarland), medio tiosulfato, citrato, sal biliar y sacarosa (TCBS, por sus siglas en inglés), agar para recuento en placa
(PCA), agar Mueller Hinton (MHA), caldo nutritivo (NB), agua destilada, disco de papel, microtips, toallas de papel y alcohol al 70%.
La extracción de C. calcitrans se adoptó de Maftuch et al. (2018). La C. calcitrans se obtuvo del Centro de Cultivo de Agua Salobre (BPBAP, por sus siglas en inglés), Jepara. El polvo de C. calcitrans se dejó en remojo en etanol al 96% (1:6). Se maceró durante 1x24 horas, se filtró y se concentró empleando un evaporador rotativo de vacío a 60ºC hasta que se convirtió en una pasta.
La biofabricación de Np-Au se inició tomando 20 mL de solución de 1 mM más 5 mL de extracto crudo de C. calcitrans, con un pH ajustado a 7.8. La mezcla se agitó durante 1 hora hasta que el color cambió a rojo rubí o púrpura, se incubó durante 24 horas y se observó periódicamente el cambio de color. Las Np-Au obtenidas se caracterizaron por UV-Vis, FTIR (Shimadzu, IRTracer-100), SEM (Thermo Fisher Scientific Phenom P-Series), TEM (Jeol JEM-1400), PSA (Biobase BK-802N) y XRD (Rigaku, Japan).
Como técnicas de caracterización se emplearon el análisis UV-Vis para determinar el valor de la resonancia de plasmón superficial (SPR, por sus siglas en inglés) y la longitud de onda máxima del gráfico de absorción estable de las Np-Au (Au0), y el
análisis PSA (Particle Size Analyzer) para determinar el tamaño de las Np-Au, en función del diámetro hidrodinámico (Dh) y del índice de polidispersidad (PDI), que indica la distribución del tamaño de las partículas.
Resultados y discusión
Resultados de la biofabricación de Np-Au mediada por C. calcitrans
El indicador inicial del éxito de la biofabricación de Np-Au viene marcado por el cambio de color de la solución de amarillo pálido a rojo rubí tras la adición del extracto de C. calcitrans y la incubación de 24 horas.
El color rojo rubí indica que se ha formado Np-Au estable. Esto coincide con la investigación de Hassan et al. (2023), según la cual el cambio de color de amarillo a rojo oscuro, a azul o púrpura indica la formación de Np-Au, fenómeno causado por la reducción de iones Au3+ a Au0 por compuestos metabolitos secundarios del extracto de C. calcitrans como: fenoles, aminoácidos, terpenoides y flavonoides (Okunowa, 2019). La reducción se produce debido a la interacción de las fuerzas electrostáticas de los grupos hidroxilo y carbonilo de los metabolitos secundarios cargados negativamente con la carga positiva de la solución de oro Au3+


Análisis UV-Vis
El color rojo rubí del Np-Au se caracterizó cuantitativamente mediante UV-vis para determinar la SPR máxima (λmax nm). La excitación de las vibraciones SPR en la solución de Np-Au provoca el cambio de color. La SPR típica de las Np-Au se sitúa entre 520 nm y 560 nm (Ee Pei et al., 2020). Basándonos en la Figura 1, se biofabricó con éxito Np-Au estable con la ayuda del agente de recubrimiento C. calcitrans, mostrando la aparición de un único máximo de absorción a λ= 533 nm.
La SPR de Np-Au que se encuentra en el rango de 530-555 nm es posible que sea esférica (Osibe y Aoyagi, 2019). La diferencia en el tamaño de las Np-Au también afecta su absorbancia. El valor de absor-
bancia de las Np-Au que miden 10-100 nm tiene un rango SPR de 517-575 nm (Manzila et al., 2020).
Análisis FTIR
Los grupos funcionales del extracto de C. calcitrans, como aminas, carbohidratos, proteínas y aminoácidos, pueden actuar como agentes de recubrimiento, reductores y estabilizadores de las Np-Au. Según los resultados de FTIR (Figura 2), existe un pico amplio de gran intensidad a 3,473 cm-1 que indica la vibración de estiramiento del -OH fenólico del extracto de C. calcitrans (Fouda et al., 2022). La absorción a 2,366.66 – 2,335.80 cm-1 indica la vibración de estiramiento de los enlaces C≡C (alquino) (Geetha et al., 2013), 2,073 cm/cm amplia



absorción con baja intensidad es la vibración de estiramiento del grupo HC≡N (Ee Pei et al., 2020). La reducción en la biofabricación de Np-Au por C. calcitrans se llevó a cabo con éxito, como indica la presencia de absorción en el número de onda 1,639 cm-1 de la vibración de estiramiento simétrico de C=O de grupos funcionales flavonoides o iones carboxilato, y 1,361 cm-1 que indica la vibración de estira-
miento de aminas alifáticas C-N, ambas originadas por el residuo de aminoácido polipeptídico del enlace Np- Au que funciona como agente de recubrimiento (estabilizador) de Np- Au (Suryakala et al., 2022), y 601 cm-1 que indica Au-O. Estas características indican que los grupos funcionales típicos de C. calcitrans se encuentran alrededor de Au0 en las Np- Au después de que se produzca la biofabricación.
Análisis SEM
La morfología de las Np-Au biofabricadas es predominantemente esférica (Figura 3a). Estos resultados concuerdan con la biosíntesis de Np-Au usando materiales naturales y poliquetos (Suryakala et al., 2022; Hassan et al., 2023). Además de ser esféricas, también presentan una morfología irregular a mayor aumento (Figura 3b).

Las nanopartículas de oro son un tipo de nanopartículas metálicas usadas como portadoras y estabilizadoras de fármacos. El método de biosíntesis de nanopartículas metálicas con plantas herbáceas, fitoplancton y poliquetos puede reducir su toxicidad.

Análisis TEM
La morfología de los resultados de la biosíntesis de Np-Au en TEM coincide con la de SEM, en la que predomina una forma redonda. También se confirmaron formas trigonales y tetragonales irregulares a aumentos de 20,000 y 80,000 veces. Mientras tanto, el tamaño de las partículas de Np-Au producidas también varía, a saber: 50, 100 y 200 nm. El tamaño de Np-Au está influido por el pH de la biosíntesis de Np-Au (pH 7.8). Cuanto menor es el pH, mayor es el
tamaño de partícula porque el grupo hidroxilo del agente de recubrimiento está protonado, lo que reduce su reactividad (Annur, 2018). Por lo tanto, la distribución del tamaño de las partículas de Np-Au varía.
Análisis PSA
Los resultados del análisis PSA muestran que el tamaño medio de partícula de las Np-Au biosintetizadas con C. calcitrans es de 8.25 nm (Figura 4), en línea con la afirmación de Osibe y Aoyagi
(2019) respecto a que el tamaño de partícula de las Np-Au oscila entre 2-20 nm. Este valor es menor que los resultados del TEM, lo cual es posible porque el TEM puede mostrar la morfología y el diámetro de las Np-Au con gran precisión. Así, el tamaño de partícula del Np-Au formado varía, a saber: 8.25, 50, 100 y 200 nm. El PDI del Np-Au se obtuvo en 0.12, lo que indica que el tamaño de partícula se distribuyó de forma polidispersa y homogénea, reforzando los resultados TEM ante-

Los metabolitos secundarios de Chaetoceros calcitrans tienen un gran potencial como agentes reductores y estabilizadores de Np-Au, a través de métodos de biosíntesis, para producir antibacterianos AHPND efectivos a bajas dosis que no causen resistencia bacteriana ni residuos, y puedan usarse a largo plazo.
riores, que mostraron una variedad de morfologías de Np-Au (redonda, trigonal y tetragonal irregular).
Análisis XRD
Según el difractograma (Figura 5), hay cuatro picos de difracción característicos de Np-Au 2θ en 31.7, 45.4, 66.2, 75.2 y 83.9, que corresponden a los patrones de difracción de Bragg en (111), (200), (220) y (311) respectivamente (Hassan et al., 2023). Existe un desplazamiento en el pico 2θ de Np-Au respecto al patrón de Np-Au según JCPDS 04-0784. Este pico indica la pureza de las nanopartículas de oro formadas, por lo que el desplazamiento puede deberse a varios factores, a saber: 1) el contenido de abundantes compuestos de metabolitos secundarios de C. calcitrans unidos a la superficie de
Np-Au, 2) la oxidación de grupos hidroxilo en el agente de recubrimiento, y 3) cambios en la red cristalina fcc (face centered cubic) de las Np-Au (Suryakala et al., 2022).
Conclusión
Basándose en los resultados de la investigación, la biofabricación se formó con éxito con la caracterización UV-vis a una longitud de onda de 533 nm, y en la prueba FTIR el grupo Au3+ fue reducido por el compuesto bioactivo C. calcitrans. Los resultados de los ensayos SEM y TEM mostraron que en las nanopartículas predominaba una forma esférica, el tamaño de partícula según el ensayo PSA fue de 8.25 nm y el ensayo XRD evidenció que se había formado una cristalización de Np-Au con la aparición de un pico de alta intensidad.
Esta es una versión resumida desarrollada por el equipo editorial de Panorama Acuícola Magazine del artículo “Characterization of Gold Nanoparticle (NP-AU)BiosynthesiswithBioreductor Chaetoceros calcitrans as a Disease Inhibitory Power of AHPND inVannamei Shrimp (Litopenaeus vannamei)”escrito por DESMIEATA,D.;SOFIYA AMALINA, DHEA PUSPITA HAKIM,ISAC MUHAMAD KAHLIL GIBRAN,AZIZAH RAIHANI PURNAMA,PRAYOGO,& ARIF HABIB FASYA - Airlangga University,Banyuwangi. La versión original, incluyendo tablas y figuras, fue publicada en OCTUBRE de 2024 en JOURNAL OF AQUACULTURE SCIENCE. Se puede acceder a la versión completa a través de https://e-journal. unair.ac.id/JoAS.





La tecnología Biofloc es un sistema acuícola sostenible que recicla los residuos y los convierte en proteínas microbianas, lo que mejora la calidad del agua y reduce el costo de alimentación. Permite el cultivo de camarones en alta densidad con un mínimo intercambio de agua, por lo que es ideal para zonas con recursos limitados. A pesar de los retos que plantea, como la demanda energética y los costos iniciales, los avances en automatización, uso de fuentes alternativas de carbono y formación de los acuicultores están mejorando su adopción a escala mundial y su potencial para transformar la acuicultura de manera sostenible.
Por: Redacción de PAM*.
La acuicultura sostenible es esencial para garantizar la seguridad alimentaria mundial, ya que permite una producción responsable y respetuosa con el medio ambiente de especies acuáticas a largo plazo. A medida que aumenta la demanda de pescado y marisco, las prácticas tradicionales suelen agotar los recursos naturales, contribuir a la contaminación y alterar los ecosistemas. La acuicultura sostenible se centra en minimizar estos impactos mediante un uso eficiente de los recursos, la reducción de la huella medioambiental y la gestión integrada de los ecosistemas. Entre las prácticas clave se incluyen los sistemas de recirculación acuícola (RAS, por sus siglas en inglés), la acuicultura multitrófica integrada (IMTA), la obten-
ción responsable de alimentos y la mejora de la gestión de residuos. El objetivo de estos métodos es aumentar la producción mientras se conserva la biodiversidad, se reducen las emisiones de carbono y se garantiza la seguridad y trazabilidad de los alimentos. Cabe destacar que la acuicultura sostenible fomenta los medios de vida rurales, aumenta el acceso a las proteínas en las regiones en desarrollo y contribuye a los Objetivos de Desarrollo Sostenible (ODS) de las Naciones Unidas, especialmente al ODS 2 (Hambre cero), al ODS 6 (Agua limpia y saneamiento) y al ODS 13 (Acción por el clima).
Una innovación prometedora dentro de la acuicultura sostenible es la tecnología Biofloc (BFT, por sus siglas en inglés). La BFT es un sistema de tratamiento de aguas residuales y reciclaje de nutrientes que aumenta la productividad de la acuicultura de manera rentable y respetuosa con el medio ambiente. Funciona manteniendo altas proporciones de carbono y nitrógeno en el agua, lo que fomenta el crecimiento de comunidades microbianas heterotróficas (bioflóculos). Estos bioflóculos convierten los productos de desecho, como el amoníaco, en proteínas microbianas que pueden ser consumidas por peces o camarones, por lo que se reduce la necesidad de alimentos externos y se limita el intercambio de agua. Este sistema es especialmente beneficioso en zonas con recursos hídricos limitados y altas densidades de población. En esencia, la BFT mejora la calidad del agua, aumenta la bio-

seguridad al reducir la carga de patógenos y mejora el rendimiento del crecimiento de especies como la tilapia y el camarón, lo que la convierte en una opción atractiva para la acuicultura sostenible, aunque requiere un control cuidadoso de parámetros como la aireación, la adición de fuentes de carbono y la calidad del agua, la reducción del impacto medioambiental y de los costos operativos. Cuando se integran en marcos de sostenibilidad más amplios, los sistemas de Biofloc contribuyen significativamente a las prácticas de acuicultura resilientes y a la seguridad alimentaria mundial.
La BFT es un sistema acuícola sostenible que mejora la calidad del agua y aporta beneficios nutricionales mediante comunidades microbianas. Recicla los residuos nitrogenados en biomasa microbia-
na mediante bacterias heterotróficas, lo que reduce la dependencia de alimentos externos y minimiza el impacto medioambiental. Es fundamental mantener una proporción equilibrada de carbono y nitrógeno (C:N) (entre 10.1 y 15:1), lo que a menudo se consigue con fuentes de carbono como melaza o azúcar. Los sistemas BFT se caracterizan por su alta densidad de población, aireación continua y limitado intercambio de agua, lo que promueve un uso eficiente del espacio y el reciclaje de nutrientes. Aunque la BFT reduce los costos de alimentación y mejora la salud de los organismos, requiere un estricto control y un gran aporte de energía, lo que limita su adopción. Los esfuerzos en investigación se centran en la automatización, las fuentes de carbono de bajo costo y la integración con sistemas como la IMTA para mejorar la eficiencia y la escalabilidad.
Mecanismos de formación de bioflóculos y su papel en el ciclo de nutrientes
El bioflóculo se forma a partir de la interacción de la materia orgánica, los sustratos y los microorganismos, como bacterias, protozoos y fitoplancton. Las bacterias heterotróficas asimilan los residuos nitrogenados y los convierten en proteínas microbianas, dando lugar a un bioflóculo rico en nutrientes, el cual contiene aminoácidos esenciales, vitaminas y ácidos grasos, lo que favorece el crecimiento y la salud de especies como el camarón y la tilapia. El bioflóculo también desempeña un papel clave en el ciclo de los nutrientes y la gestión de la calidad del agua, ya que convierte el amoníaco y el nitrito, que son nocivos, en formas seguras mediante procesos microbianos. Así, se reduce la necesidad de cambiar el agua y se mantienen niveles estables de pH y oxígeno. Los estudios
La tecnología Biofloc es un sistema de tratamiento de aguas residuales y reciclaje de nutrientes que aumenta la productividad de la acuicultura de manera rentable y respetuosa con el medio ambiente.

han demostrado sistemáticamente que la BFT mejora la eficiencia alimentaria, el crecimiento y la resistencia a las enfermedades en múltiples especies.
Comparación de BFT con los sistemas acuícolas tradicionales La acuicultura tradicional depende del intercambio frecuente de agua para gestionar los residuos, lo que a menudo provoca eutrofización y daños en el ecosistema. Por el contrario, la BFT recicla los residuos internamente, lo que minimiza los vertidos al medio ambiente (Tabla 1). Este sistema de circuito cerrado evita la proliferación de algas y reduce la prevalencia de enfermedades gracias a los efectos probióticos del bioflóculo. Desde el punto de vista económico, la BFT reduce el mayor gasto de la acuicultura, que son los costos de alimentación, al tiempo que permite una mayor densidad de población y mayores rendimientos. No obstante, los elevados costos de instalación y de energía suponen un obstáculo, especialmente en regiones con bajos ingresos. Las investigaciones en curso sobre aireación eficiente desde el punto de vista energético, integración de energías renovables e IMTA están mejorando la viabilidad y la rentabilidad del sistema. Por ejemplo, la combinación de camarones
con algas marinas ha demostrado ser eficaz para maximizar el uso de los recursos y minimizar el impacto medioambiental.
Prácticas actuales en el cultivo de camarones con BFT
La BFT ha ganado popularidad en el cultivo de camarones a escala mundial debido a su sostenibilidad y alta productividad. En China, los sistemas BFT a gran escala usan fuentes de carbono de bajo costo, como salvado de arroz y melaza, y cuentan con un sistema de monitoreo automatizado que reduce los costos de mano de obra. Estos sistemas fomentan la creación de ecosistemas autosostenibles en los que las comunidades microbianas reciclan los desechos y los transforman en bioflóculos, lo que permite el cultivo de camarones en alta densidad sin que se vea comprometida la calidad del agua.
El Indian Council of Agricultural Research (ICAR) de la India promueve activamente la BFT investigando el uso de almidón de yuca y melaza como fuentes de carbono asequibles. En particular, el noreste de Brasil ha adoptado ampliamente la BFT y explora el uso de biocarbón y residuos agrícolas como insumos. Turquía combina la BFT con la IMTA, mientras que Irán aplica la BFT en aguas salobres para minimi-
zar el uso de agua en condiciones semiáridas. Los estudios demuestran que los sistemas BFT mantienen altas tasas de supervivencia y una calidad del agua estable, incluso con densidades de población de 5,000 PL/m³.
Diseño y gestión del sistema
El éxito de los sistemas BFT depende de la forma del tanque, la aireación y el movimiento del agua. Se prefieren los tanques circulares para lograr una circulación uniforme, pero los rectangulares también funcionan si tienen un diseño adecuado. La aireación continua mediante ruedas de paletas o difusores de aire mantiene los flóculos en suspensión y los niveles de oxígeno altos. Los camarones se crían en alta densidad (100 - 450/m³), lo que requiere un control preciso de los niveles de amoníaco, nitrito y oxígeno. Una gestión eficaz de los flóculos y el uso de alimentos ricos en carbohidratos estimulan la actividad microbiana y pueden reducir los costos de alimentación hasta en un 33%.
Composición y valor nutricional de los bioflóculos
El bioflóculo está compuesto por bacterias, algas, protozoos y materia orgánica. Su valor nutricional varía en función de la dieta y de la fuente de carbono, y aporta proteí-
En la acuicultura tradicional, el intercambio frecuente de agua para gestionar los residuos suele provocar eutrofización y daños en el ecosistema. Por el contrario, la BFT recicla los residuos internamente, lo que minimiza los vertidos al medio ambiente.

nas, lípidos, minerales y vitaminas esenciales para el crecimiento de los camarones. La harina de trigo, por ejemplo, estimula las bacterias heterotróficas y favorece el crecimiento.
Aplicaciones globales exitosas
Egipto, Brasil, Indonesia e India han informado de una mejora en la supervivencia, el crecimiento y la calidad del agua de los camarones gracias al uso de BFT. En Egipto e India, la reducción de la densidad de población aumentó el rendimiento. Brasil ha demostrado los beneficios específicos para cada especie y el papel de la harina de trigo. Indonesia destaca la eficiencia económica de la BFT a pequeña escala, mientras que India ha conseguido buenos resultados combinando probióticos y BFT.
Retos en la aplicación de la BFT
La adopción generalizada de la BFT se enfrenta a retos de índole técnica, biológica y económica, que exigen soluciones específicas.

Aunque la BFT puede reducir los costos de alimentación, la inversión inicial sigue siendo una barrera. Las investigaciones están explorando sistemas energéticamente eficientes y fuentes de carbono de bajo costo, como los residuos agrícolas.
Retos técnicos
3 Altos requerimientos energéticos y costos operativos. La BFT exige aireación continua para suspender los flóculos y mantener los niveles de oxígeno, lo que supone más del 30% de los costos operativos. En regiones con tarifas eléctricas elevadas, esto limita su viabilidad. Además, en países como India o Irán no se dispone de las herramientas de monitoreo avanzado que son habituales en China gracias al internet de las cosas (IoT, por sus siglas en inglés) y al aprendizaje automático.
3 Calidad del agua y gestión microbiana. Es fundamental equilibrar la comunidad microbiana. Un sistema desequilibrado conlleva el riesgo de acumulación de residuos tóxicos. El uso de inoculantes bacterianos, como Bacillus subtilis y Saccharomyces cerevisiae, ha demostrado mejorar la calidad del agua, la salud intestinal y las respuestas inmunitarias. No obstante, la gestión de la dinámica microbiana sigue siendo compleja y específica para cada especie.
Retos biológicos
3 Riesgo de enfermedades y control de patógenos. Las altas densidades de población aumentan el riesgo de brotes de enfermedades causadas por patógenos oportunistas, como el Vibrio Aunque los probióticos y la bioseguridad ayudan, los cambios microbianos impredecibles complican el control.
3 Variabilidad de la calidad del bioflóculo. La calidad del bioflóculo varía en función de la fuente de carbono y de la gestión del sistema. Un flóculo inconsistente provoca un crecimiento y una salud subóptimos de los camarones, sobre todo en granjas a gran escala en condiciones fluctuantes.
Retos económicos
3 Costos de inversión y viabilidad. Los elevados costos de instalación y de energía dificultan su
adopción, especialmente entre los pequeños acuicultores que carecen de acceso al crédito. Aunque la BFT puede reducir los costos de alimentación, la inversión inicial sigue siendo una barrera. Se están llevando a cabo investigaciones para desarrollar sistemas energéticamente eficientes y fuentes de carbono de bajo costo, como los residuos agrícolas.
3 Aceptación del mercado. La falta de concientización de los consumidores limita la demanda de camarones BFT. Campañas educativas que hagan hincapié en la sostenibilidad, el sabor y la seguridad pueden cambiar la
percepción. Los estudios muestran que a los consumidores les preocupa más la frescura, el precio y el tamaño que los métodos de producción. Por lo tanto, la educación del mercado es menos importante que la resolución de los obstáculos técnicos y biológicos.
Perspectivas futuras
La creciente demanda mundial de productos del mar refuerza la relevancia de la BFT como modelo de acuicultura sostenible. No obstante, para su adopción generalizada son necesarios avances en tecnología, políticas y educación.

Innovación y líneas de investigación
Innovaciones como el IoT y el aprendizaje automático mejoran el control de la calidad del agua y el control microbiano en los sistemas BFT. En China, la automatización de la alimentación y el control aumentan la eficiencia. Las investigaciones están explorando sistemas BFT inteligentes que autorregulan las proporciones C:N y el oxígeno. El uso de fuentes alternativas de carbono, como microalgas, biocarbón y residuos agrícolas, mejora el ciclo de los nutrientes y reduce los costos de alimentación. Las herramientas genómicas, como la metagenómica, ayudan a identificar microbios beneficiosos y orientan el desarrollo de probióticos para la salud del sistema.
Consideraciones políticas y legales
3 Necesidad de políticas de apoyo para promover la adopción de la BFT. Los incentivos gubernamen-
tales, como subsidios, exenciones fiscales y subvenciones para la investigación, pueden facilitar el acceso de los pequeños acuicultores a la BFT. Los programas nacionales, como el de Indonesia, han aumentado su adopción.
3 Normativas medioambientales y certificaciones de sostenibilidad. La BFT se ajusta a los objetivos medioambientales y a las nuevas certificaciones. Unas directrices operativas claras y el etiquetado ecológico (como la certificación de camarones de BFT) pueden aumentar la confianza de los consumidores y el valor de mercado.
Educación y capacitación profesional
3 Importancia de los programas de formación para acuicultores y partes interesadas. La formación refuerza la confianza y las habilidades de los acuicultores para

gestionar el sistema. Los programas respaldados por la FAO en Vietnam mejoraron la supervivencia de los camarones y redujeron el costo de la alimentación. La colaboración global permite compartir las mejores prácticas. 3 Papel de las instituciones de investigación en la difusión de conocimientos sobre la BFT. Instituciones como la Universidad de Malasia en Terengganu (UMT) fomentan la adopción de esta técnica, tendiendo puentes entre la ciencia y la práctica mediante talleres y actividades de divulgación. Con un apoyo continuo, la BFT puede transformar la acuicultura para satisfacer la demanda alimentaria de forma sostenible.
Conclusión
La BFT ofrece una solución sostenible para la cría de camarones, ya que convierte los residuos en flóculos ricos en nutrientes que mejoran el crecimiento y la calidad del agua. A pesar de los retos que plantean los elevados costos iniciales y la escasez de conocimientos sobre esta tecnología, las investigaciones en curso sobre fuentes alternativas de carbono y sistemas avanzados de monitoreo están facilitando su adopción. Para maximizar el impacto global y el éxito a largo plazo de la BFT, es fundamental contar con el apoyo continuo de los gobiernos y la formación de los acuicultores.
Esta es una versión resumida desarrollada por el equipo editorial de Panorama Acuícola Magazine del artículo “APPLICATION OF BIOFLOC TECHNOLOGY IN SHRIMP AQUACULTURE: A REVIEW ON CURRENT PRACTICES, CHALLENGES, AND FUTURE PERSPECTIVES” escrito por IBER, B.T. – Joseph Sarwuan Tarka Universit y Universiti Malaysia Terengganu, IKHYO, B.C. – Nigerian Stored Products Research Institute, IKHWANUDIN ABDULLAH, M. , KASAN, N.A., MANAN, H. y MOHD NOR, M.N. – Universiti Malaysia Terengganu, ROZAIMAH SHEIK ABDULLAH, S. – Universiti Kebangsaan Malaysia y SHUKRI BIN SHAFIE, M. – Serandu Aquaponic System SDN. BHD, Malaysia. La versión original, incluyendo tablas y figuras, fue publicada en ENERO de 2025 en JOURNAL OF AGRICULTURE AND FOOD RESEARCH. Se puede acceder a la versión completa, a través de https://doi.org/10.1016/j. jafr.2025.101675

La cría de tilapias es fundamental para la seguridad alimentaria mundial, pero se enfrenta a amenazas sanitarias cada vez mayores. Comprender el papel del microbioma cutáneo en la salud y las enfermedades de los peces es esencial para desarrollar estrategias de prevención más eficaces, reducir el uso de antibióticos y garantizar la sostenibilidad de la acuicultura en países de bajos ingresos como Bangladesh.
Por: Redacción de PAM*
El crecimiento de la acuicultura y la producción de tilapia
La acuicultura es uno de los sectores alimentarios de más rápido crecimiento en el mundo, ya que suministra el 17% de las proteínas de origen animal a escala mundial y contribuye a la alimentación de más de 3,300 millones de personas. En países como Bangladesh, el pescado representa más del 60% del consumo total de proteínas de origen animal. El pescado también es una fuente fundamental de micronutrientes esenciales para las poblaciones vulnerables. A medida que aumenta la demanda, el consumo de alimentos acuáticos ha crecido un 3% anual desde 1961, superando el crecimiento de la población. La acuicultura proporciona actual-
La acuicultura es uno de los sectores alimentarios de más rápido crecimiento en el mundo, ya que suministra el 17% de las proteínas de origen animal a nivel mundial y contribuye a la alimentación de más de 3,300 millones de personas.
mente casi la mitad de los productos acuáticos del mundo, con un valor superior a USD 281,000 millones. En Bangladesh, donde más de 20 millones de personas dependen de la pesca, la acuicultura contribuye con un 3.52% del PIB y es el segundo sector de exportación más valioso después del textil. El país ocupa el tercer lugar en captura continental y el quinto en producción acuícola a nivel mundial. De los 87.5
millones de toneladas de organismos acuáticos producidos mediante acuicultura, los peces de aleta representan 57.5 millones de toneladas. La tilapia del Nilo (Oreochomis niloticus) es la tercera especie más producida, con un 7.9% del total de la acuicultura de peces de aleta, debido a su rápido crecimiento, su adaptabilidad y la favorable demanda del mercado.
Las tilapias son omnívoras, resistentes al medio ambiente y muy adecuadas para la acuicultura sostenible. Su cultivo se está expandiendo rápidamente y su producción mundial ha pasado de 0.3 millones de toneladas en 1987 a 5.9 millones en 2017. Bangladesh comen-
zó a cultivar tilapias con Tilapias de Mozambique en la década de 1950, pero el sector creció de manera significativa tras la introducción de la tilapia cultivada genéticamente mejorada (GIFT, por sus siglas en inglés) en la década de 1990. Los países asiáticos producen la mayor parte de la tilapia del mundo y son sus principales consumidores (Figura 1). En la actualidad, es el tercer pez más cultivado en Bangladesh, fundamentalmente en estanques poco profundos de tierra, y se destina en mayor medida al consumo interno. En el periodo 2019-2020, la tilapia representó casi el 10% de la producción acuícola continental del país, lo que consolidó su papel en la seguridad alimentaria y los medios de vida rurales.
El rápido crecimiento de la cría de tilapias ha aumentado su susceptibilidad a las enfermedades, que ahora constituyen una importante limitación para el crecimiento de la acuicultura, con pérdidas globales estimadas que superan los USD 6,000 millones al año. Aunque se considera que las tilapias son relativamente

El rápido cecimiento de la cría de tilapias ha aumentado su susceptibilidad a las enfermedades, que ahora constituyen una importante limitación para el crecimiento de la acuicultura, con pérdidas globales estimadas que superan los USD 6,000 millones al año.
resistentes a las enfermedades, cada vez se ven más afectadas por patógenos bacterianos, fúngicos, parasitarios y virales.
Una de las amenazas bacterianas más importantes es el Streptococcus spp, en particular Streptococcus dysgalactiae, S. iniae y S. agalactiae, que causan estreptococosis. Grandes brotes, como el que se produjo en China en 2012, han causado tasas de mortalidad de hasta el 80%, lo que ha supuesto pérdidas de más de USD 1,000 millones. Aunque los antibióticos son eficaces, su éxito depende de una administración temprana, lo que se complica por la pérdida de apetito de los peces infectados. Las vacunas, como AQUAVAC® y NORVAX®, han demostrado su utilidad para reducir el uso de antibióticos.
Otras enfermedades bacterianas son la francisellosis, la columnaris, la septicemia por Aeromonas hydrophila, la vibriosis y la edwardsiellosis. Los tratamientos varían e incluyen antibióticos, permanganato potásico, vacunas de inmersión y sul-
fato de cobre. También son comunes las infecciones fúngicas oportunistas (como, Saprolegnia spp) y los parásitos protozoarios (incluyendo, Ichthyophthirius multifiliis, Trichodina spp, y Dactylogyrus spp), y los tratamientos incluyen baños de sal y productos químicos. Las infecciones virales suponen la mayor amenaza debido a la escasez de opciones de tratamiento y a la escasa información disponible. Hay ocho enfermedades virales que afectan a la tilapia, siendo la más impactante el virus de tilapia del lago (TiLV, por sus siglas en inglés), que ha causado hasta un 90% de mortalidad en brotes a escala mundial. El TiLV se identificó por primera vez en Israel en 2014 y, desde entonces, se ha propagado al menos a 16 países, entre ellos Bangladesh, donde ha causado pérdidas significativas. Otras amenazas virales graves son el virus de la necrosis infecciosa del bazo y del riñón (ISKNV, por sus siglas en inglés), que causó altas tasas de mortalidad en Ghana y Brasil, y la necrosis nerviosa vírica
(VNN), que puede acabar con poblaciones enteras de larvas.
Una investigación en la que se analizaron muestras recogidas en criaderos tailandeses entre 2012 y 2017 reveló la presencia del TiLV en la mayoría de ellas. Antes de su descubrimiento, más de 40 países habían importado alevines y crías de tilapias de Tailandia. Estudios recientes han confirmado la presencia del TiLV en 16 países, incluidos algunos que reciben tilapias de Tailandia (Figura 2).
En Bangladesh, se ha detectado el TiLV en 13 distritos, con tasas de mortalidad que oscilan entre el 25% y el 90%. A pesar de su creciente presencia, los diagnósticos limitados, la falta de notificación y la escasez de personal calificado dificultan la gestión eficaz de las enfermedades víricas. La rápida propagación y el impacto mortal del TiLV ponen de manifiesto la urgente necesidad de mejorar la vigilancia, el diagnóstico, las herramientas y las estrategias de gestión de enfermedades en la cría de tilapias.


La clave para una acuicul tura más ef iciente y sostenible

Acompañamiento real en tu
Acompañamiento real en tu
granja granja
Planes ef icientes partiendo
Planes ef icientes partiendo de tu realidad de tu realidad
37% menos de costos, más
37% menos de costos, más
resultados resultados
Tecnología simbiótica, salud
Tecnología simbiótica, salud y ef iciencia y ef iciencia
Formación para tu equipo,
Formación para tu equipo,
impacto en tu producción impacto en tu producción
Solicite ya +34 613 87 18 60
Asesoría de nuestros expertos
www.bioaquafloc .com


Microbiomas de la mucosa superficial en la tilapia
La piel y las branquias de la tilapia actúan como barreras fundamentales contra los patógenos y están cubiertas por una capa mucosa rica en péptidos antimicrobianos, enzimas e inmunoglobulinas. A pesar de esta defensa, tales superficies albergan un entorno rico en nutrientes que favorece la presencia de microbios simbióticos adaptados al nicho. Estos microbios ayudan a proteger al pez al competir con los patógenos y mantener el equilibrio inmunitario. Las alteraciones en esta re-
lación simbiótica, conocidas como disbiosis, suelen surgir en situaciones de estrés y pueden provocar enfermedades.
Investigaciones recientes, gracias a la secuenciación de última generación, han revelado que el microbioma de la piel es distinto a la microbiota de los intestinos y las branquias, y está moldeado por la exposición constante al medio ambiente. Las comunidades microbianas de la piel están fuertemente influenciadas por la calidad del agua y suelen estar dominadas por proteobacterias, seguidas de actin-
obacterias y bacteroidetes. Si bien las bacterias generalistas del agua son comunes, en la piel de la tilapia aparecen de manera constante taxones bacterianos específicos, como Aeromonas, Cetobacterium, Pseudomonas y Comamonadaceae. Algunas cepas son patógenos conocidos (por ejemplo, A. hydrophila), mientras que otras ofrecen beneficios probióticos (por ejemplo, P. fluorescens).
Cetobacterium somerae, que se encuentra con frecuencia en peces sanos, puede desempeñar un papel clave en la síntesis de vitamina B12 y
El virus de la tilapia de lago (TiLV), que ha causado hasta un 90% de mortalidad en brotes a nivel mundial, se ha propagado desde 2014 al menos a 16 países, entre ellos Bangladesh, donde ha causado pérdidas significativas.

en la resistencia a las enfermedades. Su disminución está relacionada con las infecciones. Los tratamientos probióticos que aumentan los niveles de Cetobacterium son prometedores para mejorar la salud de los peces. Sin embargo, la función de muchos taxones básicos sigue sin estar clara y la presencia de patógenos depende de las diferencias entre cepas. Comprender los cambios en la microbiota de las mucosas puede ayudar a predecir los brotes de enfermedades. No obstante, la naturaleza variable de los microbiomas de la piel y branquias de los peces y la amplia gama de factores ambientales y del hospedador que pueden alterarlos, complican claramente el análisis de los cambios y transformaciones clave en las comunidades microbianas que pueden estar relacionados con la aparición de enfermedades para su predicción, lo que
pone de manifiesto la necesidad de investigar más a fondo.
Factores que influyen en los microbiomas cutáneos
Calidad del agua
La piel de los peces está en contacto constante con el agua, por lo que la calidad del agua es un factor clave en la configuración de sus microbiomas cutáneos. En los sistemas intensivos, la acumulación de nutrientes y toxinas (por ejemplo, nitritos y sales) altera la diversidad microbiana. Los experimentos demuestran que la exposición a productos químicos o antibióticos puede modificar las comunidades microbianas, aumentando en ocasiones taxones nocivos como Flavobacterium. Otros parámetros, como temperatura, salinidad, pH, contenido de oxígeno y presencia de algas, también influyen en la composición microbiana.
Ubicación geográfica y hábitat
Las diferencias geográficas suelen reflejar diversos factores ambientales que dan forma a las comunidades microbianas. Estudios realizados en especies de peces, como tilapia y bagre, muestran que la composición del microbioma varía ampliamente según el hábitat. Los peces criados en sistemas artificiales suelen presentar una menor diversidad y menos variación interindividual que los peces silvestres. Los diferentes sistemas de acuicultura (por ejemplo, recirculación frente a flujo continuo) también afectan a la riqueza y la estructura del microbioma.
Hospedador
Aunque el entorno domina la estructura del microbioma cutáneo, los factores relacionados con el hospedador, incluida la genética, siguen siendo importantes. Incluso los peces de la misma especie y entorno muestran variaciones individuales significativas. El vínculo genético ha relacionado microbios simbióticos adaptados específicos con los genomas de los hospedadores, lo que sugiere interacciones complejas entre la biología del hospedador y las comunidades microbianas.
Enfermedades/infecciones
En condiciones saludables, la microbiota cutánea contribuye a la respuesta inmunitaria. La disbiosis, es decir, la alteración de este equi-
librio, puede provocar enfermedades. La enfermedad suele caracterizarse por una reducción de la diversidad y un aumento de los patógenos oportunistas (Aeromonas, Vibrio y Tenacibaculum). Sin embargo, a menudo no está claro si la disbiosis es la causa o el resultado de la enfermedad. Estudios recientes se inclinan por un modelo de “patobioma”, según el cual la enfermedad surge de las interacciones entre múltiples microbios, el hospedador y el entorno, en lugar de un único patógeno, lo que pone de relieve la necesidad de comprender más a fondo los microbiomas en el ámbito de la salud acuícola.
Efectos de los antibióticos en la microbiota de los peces
Los antibióticos se usan ampliamente en acuicultura, a menudo de forma indiscriminada, especialmente en países de ingresos bajos y medios, donde la regulación es limitada. Su uso indebido preocupa por la resistencia a los antimicrobianos (AMR, por sus siglas en inglés), que se estima provoca la muerte de 0.7 millones de personas cada año. Si bien los antibióticos ayudan a tratar las infecciones, también afectan los microbiomas de los peces, lo que puede reducir la diversidad microbiana y alterar la función inmunitaria.
Los antibióticos, que se administran habitualmente a través de alimentos medicados o de forma directa en el agua de los estanques, suelen ser poco absorbibles y muy solubles, por lo que se acumulan en los entornos acuáticos. Se han detectado residuos de medicamentos como oxitetraciclina, sulfametoxazol y ciprofloxacina en ríos y estanques de toda Asia, incluido Bangladesh, lo que supone un riesgo para el medio ambiente y la seguridad alimentaria. Hasta el 75% de los antibióticos llegan al agua a través de la lixiviación o la excreción.
En los peces, los antibióticos pueden alterar los microbiomas intestinales, cutáneos y branquiales. Estudios experimentales realizados con tilapias del Nilo y peces rey de cola amarilla muestran una alteración del microbioma y un enriquecimiento de patógenos oportunistas tras la exposición a antibióticos. Sin embargo, el microbioma cutáneo puede ser más resistente que el intestinal.

El uso de antibióticos también favorece la aparición de genes de resistencia a los antimicrobianos (ARG, por sus siglas en inglés) en los microbiomas de los peces, sus heces, sedimentos y aguas circundantes. Los estudios han encontrado un aumento de la prevalencia de ARG y su asociación con elementos genéticos móviles como transposones e integrasas de fagos, que pueden facilitar la transferencia de genes. Esto pone de relieve el riesgo de una resistencia generalizada a los antimicrobianos en los sistemas acuícolas, lo que exige un uso más responsable de los antibióticos y una mayor vigilancia.
Consideraciones finales y necesidades futuras de investigación
La acuicultura desempeñará un papel fundamental en la seguridad alimentaria mundial, especialmente en los países con bajos ingresos y baja eficiencia alimentaria. Las especies resilientes y de bajo nivel trófico, como la tilapia, son esenciales para esa expansión debido a su adaptabilidad, valor nutricional y tolerancia a las enfermedades. Sin embargo, la aparición de enfermedades y su creciente pre-
valencia constituyen una amenaza importante, en particular, en países como Bangladesh, donde la cría en estanques rurales a menudo carece de medidas de bioseguridad. Para abordar esta situación, es necesario investigar más sobre los mecanismos de las enfermedades y mejorar los tratamientos, además de aplicar mejores prácticas de gestión y educar a los acuicultores sobre el uso de antimicrobianos.
Comprender los sistemas microbianos que vinculan a los peces con su entorno es esencial para optimizar su salud y prevenir enfermedades. Las superficies mucosas de los peces (piel y branquias) actúan como hábitats microbianos naturales. En los peces sanos, estos microbiomas suelen estar dominados por taxones antimicrobianos beneficiosos. Sin embargo, el estrés o los cambios ambientales pueden alterar este equilibrio y provocar enfermedades. Los avances en la secuenciación de última generación han permitido analizar en detalle la diversidad microbiana, pero se necesita más investigación para comprender la función del microbioma, en particular el papel de los virus y los bacteriófagos en los entornos mucosos.
También deben tomarse en consideración los factores asociados al hospedador y al entorno para comprender plenamente cómo se producen los cambios de la salud a la enfermedad.
Una mejor comprensión de estos microbiomas puede contribuir al desarrollo de probióticos eficaces para mejorar la salud y reducir la necesidad del uso de antibióticos. Por último, la identificación de biomarcadores microbianos conservados en las superficies mucosas puede proporcionar valiosas señales de alerta temprana sobre el riesgo de enfermedad.
Esta es una versión resumida desarrollada por el equipo editorial de Panorama Acuícola Magazine del artículo “TILAPIA AQUACULTURE,EMERGING DISEASES,AND THE ROLES OF THE SKIN MICROBIOMES IN HEALTH AND DISEASE”escrito por DEBNATH,S.C.,MCMURTRIE,J., TEMPERTON,B.yTYLER,C.R.- University of Exeter;DELAMARE-DEBOUTTEVILLE,J. yVISHNUMURTHY MOHAN,C.–World Fish,Bayan Lepas,Penang,Malaysia. La versión original, incluyendo tablas y figuras, fue publicada en ABRIL de 2023 en AQUACULTURE INTERNATIONAL. Se puede acceder a la versión completa a través de https://doi.org/10.1007/s10499-023-01117-4
www.megasupply.net • orders@megasupply.net


La acumulación de materia orgánica en el fondo de piscinas de camarones y peces puede ser un enemigo silencioso para la productividad. Megasupply, con un respaldo de más de 25 años de innovación, ofrece PromegaBiotic-f® OM en sus presentaciones PELLET y SPHERE, una respuesta biotecnológica eficaz para restaurar el equilibrio del ecosistema acuícola y mejorar la rentabilidad del productor.
Por: Redacción de PAM*
La acuicultura moderna enfrenta un desafío constante: mantener la calidad del agua y la salud de los organismos en condiciones óptimas. Uno de los problemas más persistentes es la acumulación excesiva de materia orgánica en el fondo de las piscinas producto del alimento no consumido, excretas y residuos biológicos. La acumulación de materia orgánica no solo afecta la calidad del agua, sino que genera compuestos tóxicos como amoníaco, nitrito, metano y sulfuro de hidrógeno, provocando estrés, enfermedades y mortalidad en camarones y peces.
En los últimos años, el crecimiento de la industria acuícola ha traído consigo una mayor presión sobre los sistemas de producción intensivos. Los ciclos de cultivo más cortos, el aumento en la densidad de siembra y el uso intensivo de alimento balanceado han exacerbado la acumulación de desechos orgánicos en los sistemas de cultivo. Esta situación pone en riesgo no solo la eficiencia productiva, sino también la sostenibilidad ambiental de las explotaciones.
La materia orgánica en descomposición actúa como un caldo de cultivo para bacterias patógenas, parásitos e incluso hongos que afectan
la salud de los organismos. Además, la disminución de oxígeno y el aumento de tóxicos disueltos generan un entorno hostil que limita el crecimiento y aumenta la vulnerabilidad a enfermedades. Estas condiciones, si no se gestionan adecuadamente, derivan en pérdidas económicas significativas.
Frente a este panorama, los tratamientos biorremediadores surgen como una solución innovadora, segura y eficaz. PromegaBiotic-f® OM, resultado de más de 25 años de investigación biotecnológica, representa hoy una de las alternativas más completas para enfrentar este desafío. En este artículo se destacan
los beneficios concretos de sus presentaciones PELLET y SPHERE, profundizando en sus mecanismos de acción, aplicaciones prácticas y resultados visibles.
Más allá de la superficie: ¿Por qué la materia orgánica es un problema crítico?
En cada ciclo de cultivo, los productores pueden generar entre 500 y más de 1,600 kg de materia orgánica por cada tonelada de camarón producido, dependiendo del factor de conversión alimenticia (FCA) (Tabla 1). Esta carga orgánica se deposita en el fondo, generando una serie de efectos negativos:
3 Disminución del oxígeno disuelto. La descomposición microbiana consume oxígeno, creando zonas hipóxicas o anóxicas.
3 Liberación de tóxicos. El proceso produce amoníaco, nitrito, metano y sulfuro de hidrógeno (H²S), todos ellos altamente perjudiciales para los organismos.
3 Proliferación de patógenos. Bacterias como Vibrio, hongos (Fusarium solani) y parásitos como Enterocytozoon hepatopenaei (EHP) encuentran en estos ambientes su medio ideal.
3 Incremento de enfermedades. Branquias negras y marrones, hepatopancreatitis necrotizante
(NHP, por sus siglas en inglés), entre otras patologías relacionadas con el deterioro del suelo y el agua.
Estas condiciones derivan en menor crecimiento, mayor mortalidad y reducción de la rentabilidad del cultivo.
La solución está en el suelo: la revolución de la biorremediación
La biorremediación es un proceso natural asistido mediante la inoculación de microorganismos especializados que degradan, transforman o mineralizan residuos contaminantes. En acuicultura, esta técnica se convierte en una aliada indispensable para recuperar la calidad del suelo y del agua sin generar residuos tóxicos.
PromegaBiotic-f® OM
PromegaBiotic-f® OM representa más de dos décadas de investigación y desarrollo en este campo. Sus formulaciones contienen:
3 Cinco cepas de microorganismos altamente eficaces, seleccionadas por su capacidad para mineralizar materia orgánica y degradar compuestos tóxicos.
3 Enzimas específicas que aceleran la descomposición de residuos complejos.


3 Promotores bacterianos y medio de cultivo que favorecen una rápida colonización y actividad.
El resultado es un ecosistema más limpio, oxigenado y resiliente, con menores cargas tóxicas y mayor bienestar animal.
Dos formas,un mismo objetivo con aplicaciones específicas:PELLET vs.SPHERE Aunque comparten fórmula base, PromegaBiotic-f® OM se presenta en dos formatos diferentes, PELLET y SPHERE, diseñados para adaptarse a las condiciones y equipos de cada productor.
PELLET
3 Presentación: pellets de 5 x 5 mm.
3 Aplicación: al voleo o en alimentadores automáticos.
3 Versatilidad: ideal para aplicaciones manuales en zonas con acumulación visible de residuos.
3 Ventaja: permite un control más directo del área tratada.
SPHERE
3 Presentación: esferas de 5 mm x 2.5 mm.
3 Aplicación: especialmente formulado para su uso en alimentadores automáticos.
3 Compatibilidad: mayor compatibilidad con una amplia variedad de modelos de alimentadores.
3 Ventaja: permite aplicaciones precisas y programadas junto con el alimento balanceado, maximizando su eficiencia.
Ambas presentaciones no requieren preactivación ni procesos de bioaumentación, facilitando su integración en las rutinas de manejo diario del cultivo.
Resultados que se ven y se miden
Los beneficios del uso de PromegaBiotic-f® OM han sido constatados en campo a través de múltiples ciclos reproductivos:
3 Reducción significativa de compuestos tóxicos generados por la materia orgánica: se han registrado disminuciones sostenidas de amoniaco, nitrito, sulfuro de hidrógeno y metano, directamente asociados a la biorremediación del fondo (Figura 1).
3 Mayor claridad del agua: producto de la reducción de nutrientes
La acumulación de materia orgánica no solo afecta la calidad del agua, sino que genera compuestos tóxicos como amoníaco, nitrito, metano y sulfuro de hidrógeno, provocando estrés, enfermedades y mortalidad en camarones y peces.
disponibles para floraciones algales.
3 Aumento en tasas de supervivencia: al disminuir el estrés ambiental y la carga patógena.
3 Mejora en la conversión alimenticia (FCA): reflejo de un ambiente más saludable y mayor eficiencia metabólica.
3 Disminución de enfermedades: se observa una menor incidencia de infecciones bacterianas, parasitarias y fúngicas, así como enfermedades de branquias (branquias negras y marrones) (Figura 2).
Los resultados de las pruebas de PromegaBiotic-f® OM se traducen en un impacto económico positivo y sostenible para los productores, al tiempo que promueven prácticas acuícolas más responsables.
Microbiología de precisión: el corazón del producto
La clave de la eficacia de PromegaBiotic-f® OM reside en la cuidadosa selección de sus cepas. Aunque muchas pertenezcan a la misma especie, como Bacillus subtilis, cada cepa posee características genéticas únicas que definen su comportamiento.
Las cepas elegidas para este producto fueron seleccionadas con base en:
3 Su capacidad para degradar residuos de origen animal y vegetal en ambientes acuáticos.
3 Su efecto sobre contaminantes secundarios como metales pesados, pesticidas, nitritos y H2S.
3 Su actividad antagonista frente a patógenos comunes en la acuicultura.
3 Compatibilidad sinérgica entre ellas, sin interferencias cruzadas.
3 Ausencia de riesgos sanitarios para animales, humanos y el medio ambiente.
Este enfoque de microbiología de precisión convierte
a PromegaBiotic-f® OM en un tratamiento seguro, eficaz y de alto impacto.
Aplicación sencilla, resultados consistentes
PromegaBiotic-f® OM está diseñado para facilitar su aplicación sin complicaciones operativas:
3 Dosis fraccionada: en 2-3 aplicaciones semanales por alimentador.
3 Compatible con melaza: opcionalmente se puede reforzar la acción con 10 a 25 litros de melaza por hectárea, entre 8 y 12 horas después de su aplicación.
3 Duración y estabilidad: vida útil de hasta 2 años si se almacena entre 5 y 25°C, protegido del sol y sin congelar.
Estas características garantizan un uso flexible, adaptable a la infraestructura del productor y a los diferentes estadios del ciclo productivo.

Conclusiones: una inversión inteligente en la salud del ecosistema
La acumulación de materia orgánica en las piscinas no es solo un problema ambiental: es un factor de riesgo económico que impacta directamente en la productividad, la salud animal y la rentabilidad del cultivo. PromegaBiotic-f® OM, en sus presentaciones PELLET y SPHERE, ofrece una solución efectiva basada en ciencia y diseñada para integrarse de manera simple y eficiente en las operaciones acuícolas actuales.
En un entorno cada vez más exigente, contar con aliados como Megasupply marca la diferencia. Al invertir en biorremediación con PromegaBiotic-f® OM, los productores no solo protegen sus cultivos, sino que fortalecen su compromiso con una acuicultura más limpia, sostenible y rentable.

Este artículo es patrocinado por MEGASUPPLY.
Esta es una versión desarrollada por el equipo editorial de Panorama Acuícola Magazine de “PROMEGABIOTIC-F OM PRESENTACIÓN:PELLET and PROMEGABIOTIC-F OM SPHERE”de MEGASUPPLY. La versión original fue publicada en FICHA TÉCNICA. Se puede acceder a la versión completa, incluyendo tablas y figuras, a través de https://www. megasupply.net/portafolio-de-productos/ granjas-de-camarones/probioticos-paragranjas-de-camarones/.




a un alto rendimiento en el
La harina de subproductos avícolas es rica en proteínas, con un perfil de aminoácidos similar al de la harina de pescado y carece de factores antinutricionales conocidos, lo que la convierte en un ingrediente prometedor para las dietas de peces carnívoros. En este artículo se resumen los resultados de un estudio que evalúa el impacto de su inclusión en dietas de crecimiento en agua de mar sobre la calidad del pellet, el crecimiento, el bienestar y la calidad del filete en el salmón del Atlántico.
La producción acuícola mundial se ha triplicado en las dos últimas décadas y sigue aumentando, con una acuicultura alimentada que ahora supera a las especies no alimentadas (FAO, 2022). El salmón del Atlántico (Salmo salar), la especie de pez marino más cultivada requiere proteínas de alta calidad en su dieta. La harina de pescado se ha ido sustituyendo cada vez más por proteínas de origen vegetal, como el concentrado de proteína de soya, pero este cambio plantea problemas. Los factores antinutricionales de las plantas pueden repercutir de forma negativa en el crecimiento y la salud de los peces, y la gran dependencia de proteínas vegetales de alta calidad contribuye a la com-
petencia entre alimentos destinados al consumo humano y animal. Por lo tanto, se necesitan fuentes alternativas de proteínas que sean nutricionalmente sanas, respetuosas con el medio ambiente y que apoyen una bioeconomía circular. Un enfoque de bioeconomía circular promueve la recuperación de nutrientes mediante el uso de recursos existentes como los subproductos, lo que mejora la sostenibilidad en la acuicultura. En la Unión Europea (UE), la autosuficiencia en materiales ricos en proteínas, como la harina de soya, sigue siendo baja, en torno al 28%. Los subproductos animales representan una fuente de proteína circular infrautilizada, pero prometedora. Hasta el 48% del peso
de los animales sacrificados no se destina al consumo humano, lo que supone más de 20 millones de toneladas anuales en la UE (Comisión Europea, 2024). Los subproductos animales de categoría 3 materiales de bajo riesgo pueden usarse legalmente en alimentos acuícolas desde el levantamiento en 2013 de la prohibición impuesta por la UE (Resolución 56/2013) en 2001 debido a la encefalopatía espongiforme bovina.
La harina de subproductos avícolas (PBM, por sus siglas en inglés) es un producto de categoría 3 ampliamente disponible en Europa. La PBM es rica en proteínas, tiene un perfil de aminoácidos similar al de la harina de pescado y carece de factores antinutricionales

Los resultados de crecimiento del salmón del Atlántico no mostraron diferencias entre los grupos dietéticos en cuanto a peso inicial y final, mortalidad, índice de conversión alimenticia o tasa de crecimiento específica.
conocidos, lo que la convierte en un ingrediente prometedor para las dietas de peces carnívoros. Aunque los estudios a pequeña escala muestran que la PBM favorece el crecimiento de los salmónidos, los ensayos a gran escala que reflejan las condiciones de la cría comercial son limitados. Además, la calidad física de los pellets es crucial, ya que una mala calidad conlleva el desperdicio de alimento y un aumento de costos. La calidad del filete, clave para el valor de mercado, es otro factor vital. Por lo tanto, este estudio evalúa el impacto de la inclusión de 0%, 5% y 10% de PMB en dietas de crecimiento en agua de mar sobre la calidad del pellet, el crecimiento, el bienestar y la calidad del filete en el salmón del Atlántico.
Materiales y métodos
Para este estudio, BHJ A/S (Gråsten, Dinamarca) produjo PBM a partir de subproductos avícolas de categoría 3 (espinas, pieles, vísceras) procedentes de Noruega,
Suecia y Dinamarca. Siguiendo el Reglamento 1069/2009 de la UE, la materia prima se picó (< 30 mm), se calentó a ≥ 70°C durante 20 minutos y, a continuación, se esterilizó a 100°C durante 60 minutos.
Aller Aqua A/S produjo tres dietas isoenergéticas, isolipídicas e isonitrogenadas con 0% (control), 5% y 10% de PBM en tamaños de pellets de 6 mm y 9 mm. Las dietas cumplían los requisitos nutricionales del salmón del Atlántico (National Research Council, 2011), con PBM en sustitución de otras fuentes de proteínas.
Resultados
Calidad del pellet
El análisis del pellet reveló una alta calidad física para todas las dietas con pequeñas diferencias numéricas entre dietas. La longitud del pellet fue significativamente menor para la dieta del 5% en comparación con las otras dos (p = 0.001).
Hubo una reducción significativa de la expansión entre cada una de las tres dietas (p = 0.0001), y la
reducción fue mayor para la dieta del 5% PBM que para la del 10%.
Salud de los peces y crecimiento
La salud de los peces fue evaluada periódicamente por biólogos externos durante todo el estudio. Una proporción mayor de lo esperado presentaba deformidades en la mandíbula y la columna vertebral, las cuales se encontraron por igual en todos los grupos dietéticos y no estaban relacionadas con las dietas experimentales. Por lo demás, los peces estaban en buen estado y su salud se consideró buena. Los peces de todas las jaulas recibieron tres tratamientos térmicos (31 - 32ºC) contra piojos, y dos de las jaulas alimentadas con 0% PBM necesitaron un cuarto tratamiento al final del experimento. Los resultados del rendimiento del crecimiento no mostraron diferencias entre los grupos dietéticos en cuanto a peso inicial y final, mortalidad, factor de conversión alimenticia o tasa de crecimiento específico (Tabla 1).
La harina de subproductos avícolas (PBM), una alternativa rica en proteínas derivada del procesamiento de aves, mostró resultados comparables en todos los grupos (0%, 5%, 10% de inclusión) en cuanto a rendimiento de crecimiento, bienestar, histología intestinal y calidad del producto.
Parámetros de bienestar
Los parámetros externos e internos demostraron un buen bienestar para todos los grupos dietéticos. Los peces alimentados con un 5% PBM tuvieron un factor de condición significativamente mayor (p = 0.0007) en comparación con el grupo control. Los peces alimentados con un 10% PBM presentaron una puntuación de úlceras inferior (p = 0.03) y un color de hígado más oscuro (p = 0.02) en comparación con el grupo de control alimentado con un 0% PBM, aunque las diferencias entre los grupos dietéticos fueron numéricamente pequeñas. Ningún pez del grupo del 10% tuvo úlceras, 6/30 peces tuvieron úlceras en el grupo de control y 2/30 en el grupo del 5%. Las puntuaciones de pérdida de escamas, hemorragia cutánea, cataratas, deformidades de opérculo, índice viscerosomático, grasa visceral y grasa de superficie del corazón fueron comparables entre los grupos.




Calidad del producto
Los resultados de la calidad del producto fueron similares para los tres grupos dietéticos (Tabla 2). No se detectaron diferencias en el color de los filetes ni en la concentración de pigmentos, salvo una diferencia modesta pero significativa en la medición de SalmoFan™ anterior entre el control y el PBM al 5% (control: 25.0 frente a PBM al 5% 24.4, p = 0.03). El análisis químico de los filetes reveló un aumento significativo en el contenido de materia
seca entre el grupo control y los dos grupos PBM, y una diferencia significativa en la grasa total entre el grupo control y el grupo PBM al 5%.
Histología
Las muestras tomadas antes de la exposición a las dietas experimentales, no mostraron diferencias entre los grupos dietéticos. Las puntuaciones de inflamación aumentaron a lo largo del periodo experimental con valores comparables entre los grupos dietéticos (Figura 1). En el
muestreo durante los 8 meses, los peces alimentados con 0% PBM presentaron una puntuación de inflamación significativamente mayor en comparación con los peces alimentados con 5% PBM, pero en comparación con los peces alimentados con 10% de PBM, no hubo diferencias significativas.
Discusión
El objetivo de este estudio fue evaluar el impacto de la inclusión de PBM en dietas para salmón del


Atlántico (S. salar) en condiciones de campo similares a las comerciales. La PBM, una alternativa rica en proteínas derivada del procesado de aves, mostró resultados comparables en todos los grupos (0%, 5% y 10% de inclusión) en cuanto a rendimiento del crecimiento, bienestar, histología intestinal y calidad del producto.
Investigaciones previas no encontraron efectos negativos de la PBM en el crecimiento hasta un 28% de inclusión (Hatlen et al., 2015). En este estudio, las deformidades observadas en todos los grupos se debieron probablemente a una deficiencia de fósforo en las primeras etapas de la vida, no a la dieta. El grupo con un 5% PBM mostró un
mayor factor de condición y contenido de grasa en el filete, lo cual pudo ser debido a un mayor peso final, aunque esto no se tradujo en un mayor rendimiento. La presencia de úlceras, un problema de bienestar en la cría del salmón noruego, fue menor en el grupo del 10% PMB, pero las diferencias pueden deberse a los tratamientos contra los piojos.

En general, el 83% de los peces se clasificaron como “superiores”, sin diferencias significativas entre los grupos. El contenido de grasa fue mayor en el grupo del 5%, pero la composición de ácidos grasos permaneció inalterada, probablemente debido al bajo contenido en lípidos del PBM (7.9%) y al uso constante de aceite de pescado y
En conjunto, el 83% de los peces se calificaron como “superiores”, sin diferencias significativas entre los grupos.
de canola en todas las dietas. La inclusión de harina de pescado disminuyó ligeramente con el aumento de PBM, pero no afectó el perfil de ácidos grasos.
La pigmentación, crítica para el valor de mercado, no se vio afectada a pesar de los niveles un poco inferiores de astaxantina en el grupo con 0% PBM. El color del filete no solo depende de la concentración de pigmentos, sino también del estrés y de los cambios posteriores a la muerte (Heia et al., 2009).
La inclusión de PBM no tuvo efectos negativos sobre la textura o apertura del filete. El análisis histológico no mostró un impacto significativo de la PBM en la inflamación, vacuolización o células caliciformes ectópicas en el intestino distal. Aunque la PBM podría reducir la dependencia de las proteínas vegetales y los factores antinutricionales asociados, la gravedad de la inflamación aumentó con la inclusión, lo que sugiere otras causas.
A pesar de su uso limitado en la UE, la PBM es ampliamente aceptada en otros lugares. Los obstáculos en la UE incluyen la escasa aceptación por parte de los consumidores, la variabilidad del suministro y la competencia del sector de los alimentos para mascotas. Es necesario seguir investigando para definir los niveles óptimos de inclusión y evaluar la sostenibilidad a largo plazo y las repercusiones económicas.
Conclusión
El presente estudio demostró que la PBM puede sustituir al 10% de los ingredientes proteicos convencionales en las dietas destinadas al salmón del Atlántico, sin efectos adversos sobre la calidad física del pellet , el rendimiento del crecimiento, el bienestar, la histología del intestino distal o la calidad del producto. Por lo tanto, se concluye que la inclusión moderada de
PBM en hasta un 10% es una fuente de proteína adecuada en dietas para salmón del Atlántico criado en condiciones similares a las comerciales durante la fase de crecimiento en agua de mar. Además, la inclusión de PBM en la alimentación del salmón contribuye a la economía circular mediante la transformación de subproductos de bajo valor en alimentos de alta calidad y mejorando la sostenibilidad de la acuicultura.

Este artículo está patrocinado por: NORTH AMERICAN RENDERERS ASSOCIATION (NARA)
Esta es una versión resumida desarrollada por el equipo editorial de Panorama Acuícola Magazine del artículo “POULTRY BY-PRODUCT MEAL IN DIETS FOR FARMED ATLANTIC SALMON SUPPORTS HIGH GROWTH PERFORMANCE,FISHWELFARE AND FILLET QUALITY UNDER COMMERCIALLIKE FIELD CONDITIONS”escrito por HAUG EIDE,L.- Eide Family AS,Eikelandsosen and Norwegian University of Life Sciences; FORMANOWICZ,J.,RØSVIK,M.,DJORDJEVIC, B.,yØVERLAND,M.-NorwegianUniversity of Life Sciences;KUIPER,R.y BENDIK DALE, O.- NorwegianVeterinary Institute. La versión original, incluyendo tablas y figuras, fue publicada en MAYO de 2025 en AQUACULTURE REPORTS. Se puede acceder a la versión completa a través de https:// doi.org/10.1016/j.aqrep.2025.102843

Las enfermedades bacterianas, en especial las causadas por Vibrio spp, son una de las principales causas de mortalidad en las granjas de camarones. En la actualidad, los probióticos se usan ampliamente contra las infecciones bacterianas en los protocolos de cría de larvas. Los alimentos líquidos procesados en frío de Zeigler, EZ Larva Ultra y EZ Artemia Ultra, mantienen la viabilidad de los probióticos y permiten una dosificación fiable y constante, con su correspondiente impacto en la producción y ganancias de la actividad acuícola.
Por: Peter Van Wyk y Leandro Castro*
Las enfermedades bacterianas, especialmente las causadas por Vibrio spp, son una de las principales causas de mortalidad en las granjas de camarones. Al principio de la acuicultura del camarón, los an-
tibióticos eran la principal defensa contra las infecciones bacterianas. A pesar de la creciente concientización sobre los riesgos asociados al uso rutinario de antibióticos, en particular por la aparición de cepas resistentes, muchos criaderos siguen confiando en ellos para controlar las bacterias.
Sin embargo, a partir de la década de 1990, los probióticos comenzaron a ganar aceptación, en gran parte gracias al trabajo pionero del científico australiano David Moriarty
Un método más eficaz para proteger al camarón de la infección por Vibrio consiste en administrar las bacterias probióticas directamente en el tracto gastrointestinal, es decir, incluirlas en el alimento.
(Fletcher, 2019). En la actualidad, los probióticos se usan ampliamente en los protocolos de cría de larvas en los criaderos de camarones de todo el mundo.
Aplicación de probióticos en el agua
La aplicación de bacterias probióticas en el agua de cría puede mejorar la salud de los camarones y la calidad del agua. Los estudios han demostrado que reducen los niveles de amoníaco (Kewcharoen y Srisapoome, 2019) y ayudan a inhibir el crecimiento de patógenos como Vibrio spp (Decamp et al., 2008), lo que promueve un entorno más saludable para el desarrollo larvario. No obstante, las aplicaciones en agua tienen notables limitaciones. La dosificación eficaz de probióticos a través del agua puede resultar costosa. Una tasa de aplicación típica de 3-5 ppm/día de un probiótico de 109 UFC/g da como resultado solo 3,000 - 5,000 UFC/mL. Aunque estas tasas de tratamiento son asequibles, algunos estudios sugieren que para controlar los patógenos pueden ser necesarias concentraciones de 106 UFC/ml (Ghosh, 2025), lo que aumentaría significativamente el costo del tratamiento. Incluso aumentando la adición de probióticos a 50 ppm/día, la concentración resultante sería de solo 5 × 104 UFC/ml.
Otra limitación es que los probióticos administrados a través del agua no colonizan eficazmente el intestino de las larvas de camarón. Si bien estos tratamientos pueden reducir la carga total de Vibrio en el tanque, no evitan que las larvas ingieran dosis elevadas de Vibrio asociadas a Artemia contaminada o material orgánico (Verschuere et al., 2000). Una vez ingeridos, estos patógenos pueden infectar al camarón a través del revestimiento intestinal.
Administración de probióticos dirigida al intestino
Un método más eficaz para proteger al camarón de la infección por Vibrio consiste en administrar las bacterias probióticas directamente en el tracto gastrointestinal, es decir, incluirlas en el alimento. Este enfoque dirigido permite que los probióticos colonicen el intestino y establezcan una barrera microbiana protectora que intercepta los patógenos en su punto de entrada.
Aunque es difícil medir directamente la colonización en las larvas de camarón, un estudio realizado por Zeigler y la Universidad de Filipinas Visayas demostró que, al alimentar a juveniles de Litopenaeus vannamei con alimento recubierto con probióticos Rescue (5 × 106 UFC/g de alimento), el Bacillus spp colonizó rápidamente las paredes del tracto gastrointestinal, alcanzando una

densidad de 1 × 107 UFC/g de tejido intestinal en 7 días.
Una vez establecidos en el intestino, los probióticos Bacillus limitan el crecimiento del Vibrio mediante varios mecanismos complementarios. Estos compiten con los patógenos por los sitios de adhesión y los nutrientes, secretan compuestos antimicrobianos como bacteriocinas y lipopéptidos, estimulan las respuestas inmunitarias (incluida la actividad fagocitaria) y la regulación al alza de los genes inmunitarios, además de ayudar a mantener la integridad del revestimiento intestinal, lo que reduce las oportunidades de invasión de patógenos (Ghosh, 2025; Kewcharoen y Srisapoome, 2019; Zokaeifar et al., 2012). En conjunto, estos efectos hacen que los probióticos de Bacillus sean más eficaces que los tratamientos en agua para el control a largo plazo del Vibrio en los criaderos de camarones.
Selección de cepas probióticas
Las especies de Bacillus son muy adecuadas para su uso en alimentos para camarones, ya que pueden formar esporas, lo que facilita su envasado y almacenamiento. Son muy adaptables y funcionan bien en los amplios rangos de salinidad, temperatura y pH habituales en los entornos de los criaderos. Además, las especies de Bacillus producen una gran variedad de compuestos antimicrobianos y enzimas que inhiben el Vibrio, degradan las biopelículas e interfieren en la detección del quorum (Shaheer et al., 2021; Ghosh, 2025).
Sin embargo, no todas las cepas de Bacillus son igualmente eficaces. Algunas son particularmente potentes contra el Vibrio, mientras que otras son más adecuadas para la degradación de residuos o la reducción de amoníaco. Por esta razón, la selección de cepas es fundamental. Zeigler evaluó 21 cepas de Bacillus por su capacidad para inhibir cuatro cepas patógenas de Vibrio spp (Figura 1). Las cuatro cepas con mejor rendimiento se incluyeron en el probiótico Rescue


Del mismo modo, se evaluó la capacidad de numerosas cepas de Bacillus para reducir los niveles de amoníaco y digerir la materia orgánica (Figura 2), y se seleccionaron cinco para su inclusión en el probiótico Remediate. Esta selección específica de cepas garantiza que cada producto ofrezca el máximo rendimiento en su uso previsto.
Retos de fabricación para la inclusión de probióticos
A pesar de las claras ventajas de incluir probióticos en los alimentos,
diversos factores limitan su adopción generalizada. Mantener la viabilidad de los probióticos durante el proceso de fabricación sigue siendo un reto importante. La mayoría de las bacterias no pueden sobrevivir a las altas temperaturas asociadas al procesamiento. Aunque las endosporas de las bacterias del género Bacillus son relativamente resistentes a las altas temperaturas, las esporas germinadas son muy sensibles al calor. La exposición de las esporas a la humedad de las premezclas de alimentos es suficiente para activar el proceso de germinación. Las esporas activadas son sensibles al calor y mueren. En las dietas de cría y engorde, es posible mezclar las bacterias probióticas con aceite y recubrir los pellets de alimento. Sin embargo, este método no es eficaz para las dietas de las larvas, que después de la peletización se muelen finamente y se tamizan. Recubrir con aceite estos alimentos provoca su aglomeración.
Una solución innovadora para incorporar probióticos en las dietas de los criaderos
Para resolver este problema, Zeigler desarrolló un método patentado de procesamiento en frío para añadir probióticos a los alimentos líquidos para larvas. Los productos resultantes, EZ Larva Ultra y EZ Artemia Ultra, conservan la viabilidad de las esporas y permiten una administración precisa y constante de probióticos.
Rescue, una mezcla de cepas de Bacillus seleccionadas por su actividad antivibrio, se encuentra encerrada en microcápsulas para su administración específica en el intestino. Remediate, formulado para reducir el amoníaco y los residuos

orgánicos, se incluye en la fracción líquida de ambos alimentos y se dispersa en el agua de cría al alimentar a los organismos. Ambos productos suministran esporas viables en niveles eficaces si se administran según las instrucciones.
Además de los probióticos, los alimentos líquidos de Zeigler contienen ácidos orgánicos y Vpak®, una mezcla de varios ingredientes funcionales que mejoran la función inmunitaria, optimizan el uso de los nutrientes y aumentan la resistencia al estrés oxidativo. Estos ingredientes funcionales ayudan a maximizar los beneficios generales para la salud que proporcionan las bacterias probióticas.
Prueba de eficacia
Dado que el tránsito intestinal de las larvas de camarón se produce en tan solo 20 - 30 minutos (Jones et al., 1997), algunos escépticos cuestionaron si esto dejaba tiempo suficiente para que las esporas germinaran y colonizaran el intestino. Para comprobar si los probióticos de EZ Larva Ultra y EZ Artemia Ultra podían colonizar el intestino de las larvas y mejorar su supervivencia, el Centro de Investigación Acuícola Zeigler llevó a cabo un ensayo de alimentación en el que se compararon dos formulaciones dietéticas. La dieta de control negativo no contenía probióticos, mientras que la otra incluía Rescue en las microcápsulas y Remediate en la fracción líquida. EZ Larva Ultra se administró en una proporción del 50% de la dieta durante las etapas de zoea y mysis. EZ Artemia Ultra sustituyó a los nauplios de Artemia en el protocolo durante las etapas de mysis y postlarva. El agua del tanque de cría también se trató dos veces al día con 5 ppm de Rescue (5 × 104 UFC/ml/día) durante todo el estudio. Las larvas se sometieron a una prueba de resistencia en PL9 mediante inmersión en una solución de Vibrio parahaemolyticus AHPND a una concentración de 5 × 104 UFC/ml durante 24 horas. Se registró la supervivencia tras 72 horas (Figura 3).
Los resultados fueron concluyentes. La tasa de supervivencia en el grupo de control fue del 50%. Por el contrario, la supervivencia del grupo tratado con probióticos fue del 83.3%, es decir, un 33.3% mayor. Estos resultados indican claramente

No todas las cepas de Bacillus son igualmente eficaces. Algunas son particularmente potentes contra el Vibrio, mientras que otras son más adecuadas para la degradación de residuos o la reducción de amoníaco. Por esta razón, la selección de cepas es fundamental.
que los probióticos suministrados en los alimentos líquidos fueron capaces de colonizar el intestino de los camarones y reducir significativamente su mortalidad. Además, el aumento de la protección sugiere que la administración de probióticos a través del alimento fue más eficaz que el tratamiento en agua por sí solo.
Conclusiones e implicaciones económicas
Este ensayo, junto con un número creciente de investigaciones sobre los mecanismos de acción de los probióticos, apunta a una conclusión clara: la administración de probióticos a través de la dieta de las larvas es una estrategia más eficien-
te y biológicamente eficaz para controlar las infecciones por Vibrio que su aplicación solo a través del agua.
Al actuar de forma directa sobre el intestino, las especies de Bacillus encapsuladas colonizan el tracto gastrointestinal, inhiben los patógenos y estimulan las defensas inmunitarias en los momentos en que los camarones son más vulnerables. Los alimentos líquidos procesados en frío de Zeigler mantienen la viabilidad de los probióticos y permiten una dosificación fiable y constante, algo difícil de conseguir con los alimentos secos tradicionales o las aplicaciones en el agua.
Las implicaciones para las operaciones en los criaderos son significativas. Incluso pequeños aumen-

tos en la supervivencia de las postlarvas pueden traducirse en ganancias sustanciales en la producción de juveniles y consecuentes ingresos económicos. La incorporación de dietas enriquecidas con probióticos puede reducir la mortalidad, mejorar la calidad de las larvas y disminuir la dependencia de los antibióticos, al tiempo que aumenta la bioseguridad general del sistema de producción.

Este artículo es patrocinado por: ZEIGLER BROS. INC.


Peter Van Wyk Gerente técnico de ventas global ZeiglerBros.Inc. Florida, Estados Unidos. Correo electrónico: peter. vanwyk@zeiglerfeed.com
Leandro Castro Senior Research Manager ZeiglerBros.Inc. Pensilvania, Estados Unidos.
En la industria salmonicultora, es fundamental la fase de agua dulce, justo en la cual Imenco Aqua se ha consolidado como un socio clave para los productores, ofreciendo soluciones tecnológicas de alta precisión junto a un enfoque técnico-científico que marca la diferencia en la industria, combinando innovación tecnológica, experiencia internacional y acompañamiento técnico local.
Por: ImencoAquaChile*
En la industria salmonicultora, la fase de agua dulce es un pilar estratégico que define la sanidad, robustez y potencial productivo de los peces en su etapa posterior en el mar. Asegurar procesos eficientes en alimentación y oxigenación no solo impacta en los costos operacionales, sino también en el bienestar animal y la sostenibilidad de la operación.
En este contexto, Imenco Aqua, filial chilena del holding noruego Imenco AS, se ha consolidado como un socio clave para los productores salmonicultores, ofreciendo soluciones tecnológicas de alta precisión junto a un enfoque técnico-científico que marca la diferencia en la industria.
La importancia de la fase de agua dulce: eficiencia, sanidad y tecnología aplicada
Las pisciculturas de flujo abierto, sistemas híbridos y sistemas de recirculación acuícola (RAS, por sus siglas en inglés) enfrentan desafíos crecientes: condiciones ambientales variables, aumento en densidad de cultivo y requerimientos más estrictos de bioseguridad y eficiencia. La meta es clara: criar peces sanos, con buen estado del sistema inmunológico y óptima condición corporal para garantizar su desempeño en mar abierto.

Aquí es donde Imenco Aqua ha enfocado su desarrollo, combinando innovación tecnológica, experiencia internacional y acompañamiento técnico local.
Alimentación de precisión: más eficiente, mejores resultados
Con más de tres décadas en el desarrollo de alimentadores automáticos, Imenco ofrece en Chile soluciones para cada etapa:
3 Belt Feeder: alimentadores de banda para fases tempranas, trato delicado con el pellet y de alta confiabilidad.
3 Disc Feeder: presentes en la industria desde 1988, destaca por su simpleza, durabilidad y manejo preciso del alimento.
3 Feeding Robot: sistema robotizado que alimenta estanques uno a uno, ideal para casas genéticas y programas de familias.
3 EXACT Feeding: alimentadores individuales autónomos (1 a 4 silos) con batería recargable, eficiencia energética y operación continua.
“Todos nuestros equipos son robustos y de comprobada eficiencia. Están diseñados para facilitar la alimentación con alta precisión, optimizando los indicadores productivos, como la eficiencia de conversión del alimento y la tasa de crecimiento de los peces”, explica David Ulloa, gerente general de Imenco Aqua Chile.
Oxigenación: la clave silenciosa del crecimiento y la salud
Si bien la alimentación es visible, la oxigenación es el motor invisible de la piscicultura. Sin un adecuado nivel de oxígeno disuelto, disminuye el apetito, se compromete el
“Todos nuestros equipos son robustos y de comprobada eficiencia. Están diseñados para facilitar la alimentación con alta precisión, optimizando los indicadores productivos, como la eficiencia de conversión del alimento y la tasa de crecimiento de los peces”, explica David Ulloa, gerente general de ImencoAquaChile.

metabolismo y aumenta el estrés y la mortalidad.
En esta línea, Imenco Aqua desarrolló el difusor VitaDi™, tecnología de microburbujas pequeñas y uniformes que optimiza la transferencia de oxígeno en el agua.
Los difusores VitaDi y la línea de alimentadores automáticos, han sido adoptados por más de 50 empresas en Chile y exportados desde esta unidad de negocios a Canadá, Estados Unidos, México, Ecuador, Noruega, Japón, Arabia Saudita y otros países.

El nuevo modelo VitaDi™ Flat Frame, patentado tras dos años de investigación, destaca por:
3 Eficiencia igual o superior a difusores cerámicos.
3 Operación en rangos de presión de 1 a 5 bar, ideal para estanques con baja columna de agua.
3 Vida útil sobre 5 años, gracias a su estructura de acero inoxidable y resistencia del material (manguera) hasta 60 bar de ruptura.
3 Diseño modular: formatos doble, triple y cuádruple, adaptables a distintos sistemas.

Asesoría técnica y auditorías: el respaldo que marca la diferencia
Más allá del producto, Imenco Aqua ofrece un servicio integral:
3 Evaluación de demanda metabólica: biomasa, tamaño de peces y temperatura del agua para definir la necesidad real de oxígeno.
3 Auditorías de oxigenación: visitas a instalaciones para verificar el desempeño de equipos instalados, independiente del proveedor.
3 Capacitación y soporte técnico y postventa: liderado por un equipo con grados de doctorado en biología y acuicultura, y más de 30 años de experiencia en el rubro.
“Estamos muy presentes en esta etapa crucial de la producción. Esperamos continuar avanzando en esta misma línea y seguir innovando en beneficio del sector”, agrega Ulloa.
Un aliado estratégico para el futuro de la acuicultura
Con su gama de tecnologías, Imenco Aqua apunta a reducir los costos operacionales y elevar los estándares de sostenibilidad, bioseguridad y bienestar animal, acompañando a los productores en su transición hacia sistemas más eficientes y amigables con el medio ambiente.

Este artículo es patrocinado por: IMENCO AQUA CHILE.
David Ulloa W. Gerente general
Correo electrónico: david.ulloa@imenco.com
Imenco Aqua:Smart Solutions www.imenco.com chile@imenco.com
LinkedIn: Imenco Aqua Youtube: Imenco Aqua

El éxito en el cultivo del camarón hoy exige más que satisfacer requerimientos nutricionales básicos: requiere estrategias de alimentación funcionales e inteligentes. Los alimentos funcionales ofrecen soluciones dirigidas a mejorar la inmunidad, la salud intestinal y la resistencia al estrés, conectando rendimiento y sostenibilidad, alineándose con las necesidades del productor y las expectativas del mercado por una acuicultura responsable.
Por: Alberto J.P. Nunes., Ragnhild Dragøy, Kiranpreet Kaur*
Amedida que la acuicultura mundial de camarón se expande para satisfacer la creciente demanda, la industria enfrenta desafíos cada vez mayores debido a brotes de enfermedades, factores de estrés ambiental y presiones productivas.
Estas amenazas no solo reducen las tasas de supervivencia y crecimiento, sino que también afectan la rentabilidad y la sostenibilidad a largo plazo.
Las herramientas tradicionales de manejo sanitario, como los antibióticos y tratamientos químicos, están
cada vez más limitadas por la regulación y la resistencia. En este contexto, las soluciones basadas en la nutrición están surgiendo como una poderosa línea de defensa. Ingredientes funcionales en el alimento muestran resultados prometedores al mejorar la inmunidad, la salud intestinal y la re-

sistencia al estrés en los camarones. Estos ingredientes actúan de forma proactiva, fortaleciendo a los camarones desde adentro, reduciendo la necesidad de intervenciones reactivas. Estas herramientas nutricionales están redefiniendo el manejo sanitario en la producción de camarón. Integrar estos alimentos funcionales no solo mejora el bienestar animal, sino que también responde a la demanda de los consumidores por una acuicultura limpia y responsable. A medida que la investigación avanza y las formulaciones mejoran, la nutrición se posiciona como pilar clave para la prevención de enfermedades y la optimización del rendimiento en la producción de camarón. En un sector que avanza hacia una mayor intensificación, las estrategias de alimentación inteligente ofrecen
un camino sostenible y basado en la ciencia.
Los costos ocultos de las enfermedades y el estrés
El cultivo de camarón enfrenta una batalla constante contra patógenos como Vibrio, Enterocytozoon hepatopenaei (EHP) y diversos virus que afectan el hepatopáncreas, un órgano vital para la digestión y la inmunidad. Estas amenazas biológicas suelen agravarse por factores de estrés ambiental como la mala calidad del agua, altas densidades de cultivo y alimentos contaminados con micotoxinas. El resultado: camarones debilitados, crecimiento atrofiado y grandes pérdidas económicas. Los enfoques nutricionales tradicionales, centrados solo en nutrientes esenciales (vitaminas, minerales,
aminoácidos), suelen ser insuficientes bajo las condiciones reales de cultivo. Aunque cubrir los niveles mínimos de nutrientes es necesario, rara vez es suficiente cuando los camarones están expuestos a estrés crónico y patógenos.
Aditivos y nutrientes funcionales: más allá de la nutrición básica
Para cubrir esta brecha, las formulaciones de alimento están incorporando cada vez más ingredientes funcionales que mejoran la salud intestinal, la respuesta inmune y la tolerancia al estrés. Los nutrientes funcionales pueden ser esenciales o no esenciales (vitaminas, minerales, fosfolípidos, ácidos grasos) y cumplen funciones tanto nutricionales como fisiológicas. Así, apoyan el metabolismo y las funciones del organismo con beneficios adicionales. Estos nutrientes pueden participar en el metabolismo celular, impactando en la inmunidad o la respuesta al estrés. Algunos ejemplos son nucleótidos, taurina, minerales traza (selenio, zinc), aminoácidos con funciones específicas (arginina, glutamina), ácido eicosapentaenoico (EPA, por sus siglas en inglés) y ácido docosahexaenoico (DHA) ligados a fosfolípidos, vitaminas A y D, antioxidantes liposolubles como la astaxantina y la colina, entre otros.
¿Por qué los ingredientes marinos siguen siendo importantes?
A pesar del creciente interés en alternativas vegetales y animales, los ingredientes marinos siguen siendo vitales para el rendimiento óptimo del camarón. Su perfil bioquímico único, rico en péptidos, ácidos grasos y compuestos bioactivos, mejora la palatabilidad, atracción del alimento y salud intestinal.
La harina de krill (HK), aun en bajos niveles de inclusión, ha de-
Ingredientes marinos como la harina de krill entregan beneficios funcionales difíciles de replicar por alternativas, lo que los hace indispensables en alimentos de alto rendimiento para camarón. Aun en bajos niveles de inclusión, estos juegan un rol vital en apoyar el crecimiento, la salud y la resistencia a enfermedades del camarón, especialmente bajo condiciones de cultivo comerciales.

mostrado mejorar significativamente el crecimiento, la inmunidad y la tolerancia al estrés en camarones. Investigaciones destacan el rol del HK en mejorar la supervivencia ante cambios de salinidad y temperatura, fortalecer el hepatopáncreas y potenciar las defensas antioxidantes, especialmente frente al desafío por EHP. En resumen, ingredientes marinos como la HK entregan beneficios funcionales difíciles de replicar por alternativas, lo que los hace indispensables en alimentos de alto rendimiento para camarón.
Los camarones necesitan más que solo nutrientes
La frase “los camarones requieren nutrientes, no ingredientes” puede ser técnicamente correcta, pero simplifica en exceso las complejas respuestas biológicas observadas en acuicultura. Los ingredientes marinos superan consistentemente a las alternativas vegetales, no solo por cumplir requerimientos nutricionales, sino porque entregan com-
puestos biodisponibles que activan vías fisiológicas relacionadas con la inmunidad, el metabolismo y el consumo de alimento.
Diseñando el futuro de los alimentos para camarón
El cambio generalizado hacia alimentos comerciales con mínimos ingredientes marinos merece un análisis más profundo. Aunque reducir la dependencia de harina y aceite de pescado tiene beneficios para la sostenibilidad, la exclusión casi total de otros ingredientes marinos sostenibles puede traer costos ocultos. Aun en bajos niveles de inclusión, los ingredientes marinos juegan un rol vital en apoyar el crecimiento, la salud y la resistencia a enfermedades del camarón, especialmente bajo condiciones de cultivo comerciales. Los alimentos bajos en ingredientes marinos pueden comprometer el rendimiento y la rentabilidad a largo plazo. Es importante que la industria reconsidere esta trayectoria. Los alimentos funcionales enri-
quecidos con ingredientes marinos funcionales ofrecen una solución equilibrada, combinando viabilidad económica, bienestar animal y prácticas sostenibles. Reintroducir ingredientes marinos en niveles óptimos podría ser clave para desbloquear la próxima generación de alimentos de alto rendimiento para camarón.
Aumentar ingredientes marinos requiere un enfoque en su sostenibilidad
Está demostrado que incorporar ingredientes marinos proporciona beneficios importantes en salud y producción en la camaronicultura. Estos efectos varían según la fuente del ingrediente marino. Ingredientes de alto rendimiento que son efectivos en bajos niveles de inclusión representan alternativas sostenibles.
Al adquirir ingredientes marinos, si estos son provenientes de pesca extractiva, se debe analizar su manejo y producción junto con su efecto en el rendimiento. Pesquerías bien gestionadas previenen la so-
A medida que la investigación avanza y las formulaciones mejoran, la nutrición se posiciona como pilar clave para la prevención de enfermedades y la optimización del rendimiento en la producción de camarón.

Esquemas de certificación como el del Marine Stewardship Council (MSC) evalúan y califican empresas de extracción y producción para garantizar que sus operaciones sean sostenibles.

brepesca y aseguran la preservación de los recursos naturales.
Esquemas de certificación como el del Marine Stewardship Council (MSC) evalúan y califican empresas de extracción y producción para garantizar que sus operaciones sean sostenibles. La pesquería de krill está entre las mejor evaluadas por el MSC, asegurando un manejo responsable de la biomasa marina. Otras medidas importantes de sostenibilidad involucran empresas que reducen su huella ambiental y garantizan buenas condiciones laborales. Al integrar ingredientes marinos efectivos en bajos niveles de inclusión, con operaciones sostenibles demostradas, la camaronicultura puede mejorar su rendimiento sin comprometer la biodiversidad.
La nutrición funcional es el futuro
El éxito en el cultivo del camarón hoy exige más que satisfacer requerimientos nutricionales básicos:
requiere estrategias de alimentación funcionales e inteligentes. A medida que aumentan las presiones por enfermedades y estrés ambiental, la nutrición convencional se queda corta. Los alimentos funcionales ofrecen soluciones dirigidas a mejorar la inmunidad, la salud intestinal y la resistencia al estrés. Estas formulaciones avanzadas van más allá de la promoción del crecimiento; apoyan activamente la resiliencia del camarón y reducen la dependencia de antibióticos y tratamientos químicos.
En los sistemas de cultivo intensivo actuales, la nutrición funcional no es opcional: es esencial. Conecta rendimiento y sostenibilidad, alineándose con las necesidades del productor y las expectativas del mercado por una acuicultura responsable. A medida que la industria evoluciona, adoptar el diseño de alimentos funcionales no solo es una buena decisión: es el futuro del manejo sanitario en el cultivo de camarón.

* Dr. Alberto J.P. Nunes. Instituto de Ciências do Mar (Labomar), Brazil.
Ragnhild Dragøy, Ph.D., MBA. Aker QRILL Company.
Kiranpreet Kaur Ph.D. Aker QRILL Company.

Los aditivos microbianos en alimentos acuícolas han sido ampliamente documentados y su eficacia ha demostrado mejorar la salud y el rendimiento animal, así como la productividad y la rentabilidad de las granjas. Los camarones y peces en engorde pueden beneficiarse de ellos para mejorar la salud digestiva, la robustez y el rendimiento cuando se aplican de forma continua. Optiwall y Yela Prosecure ofrecen soluciones fundamentales asequibles para todas las especies en todas las etapas, con un rápido retorno de la inversión en el campo.
Por: Lallemand Animal Nutrition*
Los probióticos y derivados de levadura, cuidadosamente desarrollados, pueden mejorar la resistencia de camarones y peces frente al manejo y las condiciones adversas de cultivo, mejorar el estado inmunitario y la resiliencia a las enfermedades, además de modular de forma positiva la microbiota del sistema digestivo para una mejor salud y eficacia digestiva. En conjunto, los ingredientes de base microbiana son versátiles y pueden contribuir favorablemente al costo de producción, así como al volumen (mejor crecimiento, eficacia alimenticia y super-

Para proteger el rendimiento y la rentabilidad, Lallemand desarrolló ingredientes innovadores que, al aplicarse junto con buenas prácticas de cría, hacen frente a los desafíos diarios del cultivo.
vivencia), con un mayor retorno de la inversión.
Hoy en día, estos ingredientes bacterianos y de levadura se suelen aplicar en alimentos específicos, como fórmulas para larvas y juveniles, dietas de transferencia o paquetes de salud; por lo tanto, se enfocan en períodos críticos donde su contribución es particularmente relevante. Sin embargo, los organismos están expuestos constante y repetidamente a diversos desafíos, como condiciones ambientales variables, manejo, presión de patógenos y modificación del perfil nutricional del alimento, que impactan, en particular, el estado inmunitario y la microbiota del sistema digestivo.
¿Podemos promover eficazmente la salud y el rendimiento con ingredientes microbianos de base?
Para proteger el rendimiento y la rentabilidad, Lallemand desarrolló ingredientes innovadores que, al aplicarse junto con buenas prácticas de cría, hacen frente a los desafíos diarios del cultivo. Su moderado costo de inclusión permite su uso durante todo el ciclo.
Optiwall, una solución fundamental y versátil para mejorar la robustez y el rendimiento Por ejemplo, Optiwall, desarrollado por Lallemand Animal Nutrition, se centra en ofrecer una solución
altamente rentable para uso continuo. Optiwall presenta características únicas de pared celular de levadura, incluyendo, en particular, una larga longitud de cadena de manano oligosacáridos (MOS) para una bioactividad superior (Figura 1.a). Esto garantiza una mejor capacidad de unión a patógenos en el lumen intestinal (Figura 1.b), así como una potente inmunomodulación. Las consecuencias para camarones y peces son una mejor regulación de la presión de patógenos en el tracto digestivo, una mejor salud intestinal y un mejor rendimiento animal en condiciones reales. Este producto de pared celular de levadura es el resultado de años de optimización e investigación científica en la
interfaz entre la biotecnología de la levadura, la fermentación, y la salud y el rendimiento de los organismos acuáticos. Como resultado, Optiwall es un producto rentable con una excelente consistencia entre lotes y una especificación garantizada, que puede usarse como ingrediente fundamental para promover continuamente la salud y el rendimiento en acuicultura durante todo el ciclo de producción.
Mejorar el rendimiento y la rentabilidad en condiciones desafiantes
Se realizó una prueba de 60 días en México, en condiciones similares a las de una granja, con juveniles de Litopenaeus vannamei. El sistema


Optiwall es un producto rentable con una excelente consistencia entre lotes y una especificación garantizada, que puede usarse como ingrediente fundamental para promover continuamente la salud y el rendimiento en acuicultura durante todo el ciclo de producción.
experimental consistió en hapas con acceso al suelo, ubicadas dentro de un estanque comercial, con una población de 25 camarones/m². Se probaron dos dosis de Optiwall en el alimento frente a un control (750 y 1,500 g de Optiwall/tonelada de alimento peletizado). Durante la prueba, los camarones fueron expuestos a las siguientes condiciones ambientales adversas: el nivel promedio de oxígeno disuelto (OD) en el agua fue de 2.6 ppm por la mañana (mínimo 1.6 ppm de OD); alta salinidad (promedio de 42 ppt) y un rápido descenso de la temperatura de 32.5°C el día 45 a 23.9°C el día 49. El crecimiento fue similar entre las dietas, con 14.7 g de peso corporal final en todos los grupos,
pero la supervivencia fue numéricamente mayor en los tratamientos con Optiwall (78.4%, 84.0% y 83.2% para el grupo control, Optiwall 0.75 y Optiwall 1.5, respectivamente), lo que resultó en una ganancia de biomasa significativamente mayor en los grupos suplementados (Figura 2.b). Además, la tasa de conversión alimenticia (TCA) mejoró significativamente en ambos grupos con Optiwall, lo que indica un mejor rendimiento del alimento. Gracias a la mejora en el rendimiento y la TCA, la suplementación con Optiwall aumentó la rentabilidad en un 15%.
Otra prueba realizada en Brasil, con una mayor densidad (100 camarones/m²) y dosis de suplementación (2 kg de Optiwall/tonelada
de alimento), confirmó los beneficios de Optiwall, con un mayor peso corporal final (Control: 13.6 g; Optiwall: 13.9 g), mejor supervivencia (Control: 86.9%; Optiwall: 88.5%) y rendimiento (Control: 954 g/m²; Optiwall: 1086 g/m²). Como resultado, el retorno de la inversión en Optiwall fue de 12:1 (USD 12 de ganancia por cada USD invertido en Optiwall).
Finalmente, una prueba realizada en una granja comercial en India confirmó aún más los beneficios de Optiwall cuando se aplica continuamente a una dosis de 1 kg/tonelada de alimento, lo que resultó en una mejora significativa del peso corporal final, la supervivencia, el factor de condición y la TCA.

En conjunto, estos hallazgos muestran que Optiwall aplicado continuamente a un nivel moderado de inclusión, mejora el rendimiento y la resiliencia durante el engorde de camarones en diversas condiciones, lo que resulta en un retorno de inversión positivo.
Optiwall también mostró claros beneficios en los peces. Se realizó una prueba de dosis-respuesta de 9 semanas con juveniles de lubina europea, donde se evaluaron tres niveles de inclusión de Optiwall (1.5; 3.0 y 4.5 kg/tonelada) frente a un grupo control sin suplemento. Los peces se criaron inicialmente en condiciones óptimas durante 43 días (Fase I) y, posteriormente, se expusieron durante 20 días (Fase II) a una combinación de desafíos: bajo nivel crónico de oxígeno disuelto (< 50% de saturación), alta densidad de cría (> 15 kg/m³) y factores de estrés agudos repetidos (emersión en aire de 1 minuto dos veces por semana).
Durante la prueba, la tasa de crecimiento específico (SGR, por sus siglas en inglés) (Figura 3.a) y la TCA (Figura 3.b) mejoraron significativamente, con una clara respuesta a la dosis al aumentar el nivel de inclu-
sión. La degradación de la TCA observada durante las condiciones adversas se mitigó de forma evidente con la dosis más alta de Optiwall También mostró beneficios significativos en la robustez de la piel. La excreción de moco cutáneo aumentó un 33% con el nivel más alto de suplementación (Figura 3.c), y se observaron propiedades antimicrobianas superiores con la suplementación de 3 kg/T (Figura 3.d).
En general, la suplementación con Optiwall mejoró el crecimiento y el rendimiento alimenticio, además de reforzar las barreras mucosas intestinales (no se muestra aquí) y cutáneas al exponerse a una combinación de condiciones ideales y desafiantes que imitaban las condiciones de campo.
Yela Prosecure, una fuente de proteína altamente digestiva y probióticos para la acuicultura Yela Prosecure es una levadura hidrolizada entera específicamente diseñada, que contiene un 42% de proteínas altamente digestivas y entre un 38% y un 40% de fibras funcionales.
El proceso de hidrólisis, perfectamente controlado y óptimo, da
como resultado que el 94% del contenido proteico del producto consiste en aminoácidos libres y péptidos pequeños, lo que garantiza una alta biodisponibilidad, digestibilidad y rápida absorción.
La cinética de absorción de proteínas a menudo se pasa por alto, a pesar de ser fundamental para el valor biológico real de una fuente proteica. Esto ocurre especialmente en dietas formuladas para especies con tiempos de digestión y tránsito cortos, como los camarones peneidos y diversos peces. A diferencia de la levadura seca inactivada entera, que presenta un nivel similar de proteína cruda, pero una cinética de absorción deficiente, Yela Prosecure presenta un 90% de digestibilidad instantánea, superior a la de otras fuentes proteicas clásicas (más detalles y explicaciones a solicitud). Además, la fuente de nitrógeno de bajo peso molecular de Yela Prosecure proporciona funcionalidades adicionales, como potenciar la palatabilidad y beneficios directos para la salud intestinal, a la vez que actúa como fuente de nutrientes para la microbiota endógena. Así mismo, la fracción insoluble (fibras funcionales) del producto actúa como fuente

prebiótica para la microbiota intestinal, garantizando así una salud digestiva equilibrada.
Se realizó una prueba de 10 semanas con lucioperca (Sander lucioperca) en un sistema de recirculación acuícola (RAS, por sus siglas en inglés). Se empleó una dieta estándar rica en harina de pescado como control (FM). Se formularon dos dietas sustituyendo el 30%
y el 60% de la harina de pescado por harina de soya (SM30, SM60) como fuente alternativa de proteína. Estas dos formulaciones “modernas” se probaron posteriormente, cada una suplementada con 20 kg/T de Yela Prosecure (SM30+YPS y SM60+ YPS). Se evaluaron cinco grupos experimentales por cuadruplicado, con alimento diario hasta la aparente saciedad.

Como era de esperar, la incorporación de harina de soya redujo el crecimiento (Figura 4.a) y la TCA (Figura 4.b), así como la supervivencia (Figura 4.c), en comparación con la dieta control rica en harina de pescado. Estas pérdidas de rendimiento inducidas por la harina de soya se mitigaron claramente con la incorporación de Yela Prosecure (SM30+ YPS y SM60+ YPS), manteniendo el crecimiento, la TCA y la supervivencia en los niveles observados en el grupo control. Este estudio, también documentó que Yela Prosecure mitigó el impacto negativo de las dietas ricas en harina de soya sobre la función hepática y la respuesta inmunitaria inespecífica mediante diversos biomarcadores plasmáticos (no se presenta aquí).
Se realizó otro ensayo de 10 semanas con dorada (Sparus aurata) en un sistema de flujo continuo. Se usó un alimento estándar como


El uso continuo de Optiwall, a un nivel moderado de inclusión, mejora el rendimiento y la resiliencia durante el engorde de camarones en diversas condiciones, lo que resulta en un retorno de inversión positivo.
control (47.6% de proteína cruda) y se formularon dos dietas de prueba sustituyendo un 2% de harina de pescado por un 2% de Yela Prosecure, con un nivel de proteína equilibrado con otras fuentes proteicas (YPS IsoP; 47.6 % de proteína cruda) o no (YPS LowP; 45.7 % de proteína cruda).
Ambas dietas formuladas con Yela Prosecure resultaron en una mayor SGR (significativa para YPS IsoP, Figura 5.a) y un mayor consumo de alimento (Figura 5.c), mientras que con la dieta YPS IsoP se observó una menor TCA (Figura 5.b). Esto demuestra el valor nutricional superior de Yela Prosecure en comparación con la materia prima tradicional.

Se realizó un ensayo de 60 días en México con camarón blanco del Pacífico (L. vannamei) a una densidad de 25 camarones/m² en hapas junto a un estanque comercial. Se probaron tres dietas: un control comercial sin suplemento de levadura hidrolizada (35% de proteína, muy baja harina de pescado, ácidos orgánicos, zeolita enriquecida con cobre y un probiótico, isodosis en todas las dietas) y la misma dieta suplementada con 1% de una levadura hidrolizada de la competencia de mayor venta o 1% de Yela Prosecure. El crecimiento y la supervivencia fueron similares en todos los tratamientos. Sin embargo, los camarones alimentados con Yela Prosecure tuvieron una TCA significativamente menor (Figura 6). Combinando los resultados técnicos y los costos, la aplicación del producto de la competencia resultó en un retorno de la inversión negativo (-0.8:1), mientras que el uso de Yela Prosecure resultó en un ROI positivo de 3.3:1, lo que indica una mayor ganancia financiera para el usuario.
Conclusión
Preparar a los organismos para los desafíos diarios es fundamental para garantizar el rendimiento deseado
durante la fase crítica de engorde. Los camarones y peces en engorde pueden beneficiarse de ingredientes microbianos seleccionados para mejorar la salud digestiva, la robustez y el rendimiento cuando se aplican de forma continua. Optiwall y Yela Prosecure ofrecen soluciones fundamentales asequibles para todas las especies en todas las etapas, con un rápido retorno de la inversión en el campo. Para períodos específicos, se recomienda el uso de otros ingredientes microbianos diseñados para apoyar funciones biológicas específicas contra riesgos específicos.

Para más información:
François Cellier
Technical deployer Aquaculture
Lallemand Animal Nutrition
Correo electrónico: fcellier@lallemand.com

Un sistema acuático completo depende en gran medida de los microbios que residen en el mismo y la microbiota intestinal. La administración de probióticos a peces y camarones, como Mainstanq y su acción “biorremediadora” en el fondo del estanque de cultivo, contribuye al mantenimiento de la calidad del agua y, en consecuencia, a la salud y el bienestar de las especies acuáticas.
Por: Mario Aguirre*
La interacción patógeno, hospedero y ambiente, muestra el manejo integral que debe aplicarse a cualquier sistema de cultivo de organismos acuáticos, tomando especial relevancia el ambiente, sobre todo en sistemas abiertos de cultivo donde el manejo del estanque se enfoca en el control de la calidad de agua
y suelo, así como en el control biológico del ambiente (Tabla 1).
La calidad del agua está estrechamente relacionada con la salud de los organismos acuáticos. Las bacterias heterótrofas en el agua desempeñan un papel importante en la desintegración de la materia orgánica y el ciclo de los nutrientes. Además, su población modula
en gran medida la microbiota intestinal de la vida acuática. Un sistema acuático completo depende de manera sustancial de los microbios que residen en el mismo y la microbiota intestinal, manteniendo la salud y el bienestar de las especies acuáticas mediante la regulación de la defensa antibiótica, la mitigación de patógenos y la absorción de nu-

trientes (Goh et al., 2022). Factores como la demanda de productos acuáticos, rentabilidad y eficiencia han impulsado el desarrollo de líneas genéticas de camarones de alto crecimiento, así como la implementación de nuevas tecnologías de alimentación, monitoreo remoto de los parámetros calidad de agua e incremento de las densidades de cultivo. El cultivo de tilapia también ha sufrido el impacto de enfermedades de origen bacteriano y viral, impulsando al acuicultor a una mejor eficacia de los sistemas de cultivo. En ambos segmentos acuícolas existen desafíos de las capacidades de cargas, aumentando la presión sobre los procesos de cultivo y favoreciendo el riesgo de brotes de mortalidades, causados principalmente por virus y bacterias, aunado a altas cargas de desechos metabólicos. De igual manera, el riesgo de resistencia generada por los antibióticos ha mermado su uso y limitado alternativas de contención y exclusión de patógenos.
Está documentado que la adición de bacterias probióticas a los
sistemas de cultivo y dieta de peces o camarones, puede mejorar la calidad del agua, por lo que las bacterias probióticas desintoxican la misma, haciéndola adecuada para los organismos de cultivo (Kuebutornye et al., 2019). En cuanto a la definición de probióticos, surgen términos que tienden a confundir sobre la naturaleza de estos y su función, por lo que es importante aclararlos.
¿Quién es quién…?
Probióticos: microrganismos que confieren beneficios a huésped y ambiente. Brindan mejores resultados como consorcios bacterianos benéficos, se usan comúnmente como suplementos terapéuticos, profilácticos y de crecimiento en la acuicultura. Los probióticos incluyen bacterias Gram positivas, bacterias Gram negativas y otros organismos como levaduras, bacteriófagos y algas unicelulares. Las bacterias se han empleado ampliamente como cepas probióticas que, por lo general, están presentes en el intestino de peces sanos como Lactobacillus y bifidobacterias. Algunas bacterias

Gram positivas, tales como Bacillus spp, Enterococcus spp y Streptococcus spp, actúan como cepas probióticas comunes y parte principal de la microbiota gastrointestinal. Las bacterias anaerobias facultativos Gram negativos son dominantes en el tracto gastrointestinal de peces e invertebrados marinos, así como los anaerobios simbióticos predominan en la parte posterior del tracto digestivo de los peces herbívoros tropicales (Das et al., 2017).
Prebióticos: componentes alimentarios no digeribles que benefician la colonización de ciertas bacterias, como los probióticos (salud intestinal). Gibson et al. (citado por Das et al., 2017), informaron que un ingrediente alimenticio que actúa como prebiótico debe poseer los siguientes criterios: mostrar resistencia a la acidez gástrica, hidrólisis por enzima digestiva, fermentación por microflora gastrointestinal y aumentar la abundancia de bacterias intestinales relacionadas con la salud. Ejemplo: polisacáridos, manano oligosacáridos (MOS) e inulina, entre otros.
Simbióticos: combinación de probióticos y prebióticos en un mismo producto, con efectos sinérgicos y complementarios sobre el huésped. Estos aditivos tienen efectos estimulantes del crecimiento e inmunoestimulantes (Khanjani et al., 2024).
Postbióticos: factores solubles producidos por bacterias vivas o liberados durante la lisis celular. Estos factores comprenden la producción bacteriana y subproductos metabólicos secretados durante el crecimiento o el proceso de fermentación. Subproductos del metabolismo de probióticos.
Aplicación de los probióticos en acuicultura
Probióticos alimenticios, vía oral con el alimento, mejoran el equilibrio de la microflora intestinal. Los microbios intestinales mejoran la resistencia a las enfermedades y al estrés, así como la digestión. Son promotores del crecimiento, reproducción, función inmune y fuente de nutrientes. Los componentes activos de los probióticos abarcan compuestos antagónicos que proporcionan antivirales, antibiopelículas, antivirulencia, antidetección de quórum sensing, antibacterianos, antifúngicos, antiinflamatorios y efectos sideróforos (Figura 1).
Desde el punto de vista tecnológico, los probióticos desarrollados para su administración a peces y camarones a través del agua de cría, deben estar formulados con ciertas características específicas, tales como: buena estabilidad en el agua, control de la flotación en los tanques/ estanques y alta concentración que favorezca una dosis diaria baja.
Probióticos biorremediadores, se aplican en columna de agua y/o fondo del estanque. Favorecen o cambian la comunidad microbiana en el entorno de los organismos en cultivo, contribuyen a la degradación de los productos de desechos orgánicos y a la eliminación de sustancias tóxicas y olores orgánicos del estanque. Las bacterias probióticas, como Bacillus spp, pueden convertir la materia orgánica en CO² para que los efluentes orgánicos se puedan minimizar en el sistema acuático. Mediante el uso de bacterias nitrificantes, la cantidad de nitrato, nitrito y amoníaco se reduce en gran medida (Das et al., 2017).
Cepas de bacterias probióticas estudiadas por su efecto promotor de crecimiento en camarón Goh et al. (2022), en revisión efectuada sobre el uso de probióticos en acuicultura, reportan que se han estudiado más de 20 géneros de microorganismos por su efecto de promoción del crecimiento en camarones. Entre los probióticos, Bacillus fue el género más estudiado y ampliamente aplicado en la cría de estos organismos. La Tabla 2, presenta una lista de microorganismos que muestran efectos de promoción del crecimiento en camarones, el cual se evaluó mediante parámetros como tasa de crecimiento es-


pecífico (SGR, por sus siglas en inglés), crecimiento diario promedio (GMD), tasa de ganancia de peso (WGR), factor de conversión alimenticia (FCR) y eficiencia alimenticia (FE). La mayoría de las cepas mostraron funciones multifacéticas. Las especies de bacterias probióticas evaluadas representan a los candidatos para reemplazar a los promotores de crecimiento (AGP, por sus siglas en inglés). En este sentido, se justifica más investigación, en particular para descifrar el mecanismo subyacente al efecto de promoción del crecimiento de los probióticos, antes de su implementación comercial a gran escala.
Importancia de las bacterias del género Bacillus como biorremediadores (Hlordzi et al., 2020)
Las especies de bacterias del género Bacillus han demostrado una gran capacidad en el mantenimiento de la calidad del agua en la acuicultura, que es simple y rentable. La eficiencia de estas bacterias en la modulación de la calidad del agua depende de factores como el modo de aplicación, oxígeno disuelto, pH, temperatura, fuente de nutrientes, tipo de cepa y los iones metálicos. Entre los beneficios de las especies de bacterias del género Bacillus se encuentran:
3 Reducción de amonio y nitritos. El nitrógeno amoniacal total (TAN, por sus siglas en inglés), N-NO³, N-NO² y nitrógeno Kjeldahl total (TKN), son usados por los Bacillus para su metabolismo, contribuyendo a la eliminación de nitrógeno de la columna de agua. La nitrificación del NH4+ descarga iones de hidrógeno que contribuyen al proceso de acidificación del agua acuícola.
3 Reducción de materia orgánica. Usan fuentes orgánicas e inorgánicas de carbono para crecer reduciendo la acumulación de partículas, además de disolver el carbono orgánico. Mineralizan y consumen oxígeno disuelto.
3 Modulación de oxígeno disuelto (OD) y pH. El CO² y los nutrien-
tes procedentes de la mineralización, favorecen la fotosíntesis del fitoplancton que, a su vez, consumen CO² libre y bicarbonatos. La fotosíntesis aumenta el OD y carbonatos, los cuales liberan OD en la hidrólisis. Los carbonatos aumentan el pH del agua en la hidrólisis.
3 Reducción de fosfato y sulfuro de hidrógeno. Usan fosfato para su metabolismo reduciendo su nivel y equilibran afloramientos de algas, disminuyendo la presencia de cianobacterias. Las cepas del género Bacillus disminuyen el sulfuro de hidrógeno.
Productos del metabolismo de las bacterias del género
Bacillus
Muchas especies del género Bacillus son importantes debido a su capacidad para producir antibióticos/ metabolitos que tienen efectos antagónicos contra microorganismos patógenos. Se han empleado en la medicina y la industria farmacéutica para controlar diversas enfermedades en humanos, animales y plantas, como agente de control biológico, debido a su capacidad para sintetizar una amplia variedad de metabolitos con actividad antimicrobiana. Son fuentes de antibióticos baratas, no patógenas y no tóxicas (aunque no todas) y más eficaces, por lo cual, deseables para la producción comercial y se han utilizado
experimentalmente para controlar bacterias patógenas en peces a lo largo de los años. La mayoría de las especies de Bacillus usadas como probióticos en peces y camarones incluyen B. subtilis, B. licheniformes, B. pumilus y B. amyloliquefaciens (Kuebutornye et al., 2019). A continuación, se presentan algunas especies de Bacillus y productos derivados de su metabolismo:
3 B. licheniformis : bacitracina (Hussein & Al-Janabi, 2006).
3 B. subtilis: subsporina, bacillosina y subtilina.
3 B. pumilus: pumilin, ayuda a inhibir bacterias en el tracto digestivo.
3 B. amyloliquefaciens: produce una proteína antibiótica natural barnasa.
3 B. megaterium: penicilina amidasa. Antimicótico y antiviral.
Estos compuestos mejoran la supervivencia de estas bacterias en un medio ambiente competitivo con otros microorganismos donde las fuentes de energía son limitadas. La mayoría de las especies de Bacillus puede degradar de forma efectiva una serie de biopolímeros (proteínas, almidón, pectina, etc.). Se les concede un rol significativo en los ciclos biológicos del carbono y nitrógeno. Los Bacillus pueden tolerar severas condiciones ambientales, como alta y baja temperatura, altos y bajos pH e, incluso, salinidades altas, dada su característica de espo-
rulación. Por lo general, la proteasa, la amilasa, la tripsina y la lipasa son las principales enzimas digestivas moduladas por las especies de Bacillus (Figura 3).
Presentación de los probióticos Los probióticos para acuicultura se comercializan en diversas formas, adaptándose a las diferentes necesidades de aplicación en granjas, laboratorios y plantas de alimento. Las presentaciones más comunes son:
3 Polvo o liofilizado: los microorganismos probióticos se cultivan y, luego, se someten a un proceso de liofilización (secado por congelación) o secado por aspersión. Son fáciles de almacenar, transportar y dosificar. Se pueden mezclar con el alimento mediante un adherente. Igualmente, se pueden disolver en agua y aplicar al agua de cultivo.
3 Líquido: los microrganismos se mantienen en una suspensión líquida, pueden ser cultivos vivos y activos, o concentrados que necesitan ser diluidos. Permiten una acción más rápida de los microorganismos al ser aplicados de forma directa al agua de cultivo. La vida útil puede ser más limitada y algunos requieren refrigeración.
3 Gránulos o pellets: los probióticos se incorporan directamente en gránulos o pellets, como parte de


La eficiencia de las bacterias del género Bacillus en la modulación de la calidad del agua depende en gran medida de factores como el modo de aplicación, oxígeno disuelto, pH, temperatura, fuente de nutrientes, tipo de cepa y los iones metálicos.


un alimento complementario o una premezcla. Facilitan la ingesta por parte de los organismos en cultivo.
3 Tabletas: facilitan la acción directa de las bacterias sobre el fondo del estanque, donde las mismas se disgregan liberando los microrganismos probióticos, los cuales se activan al contacto con el agua.
Las especies del género Bacillus forman esporas bajo condiciones adversas. Esta característica facilita su comercialización y uso como probióticos por su rápida activación en condiciones favorables, como al entrar en contacto con el agua (Figura 4). Esta característica y las indicadas en la Figura 3, les convierte en excelentes candidatos para biorremediación y uso en salud intestinal.
Dosificación de los biorremediadores
Los fabricantes especifican la cantidad de unidades formadoras de colonias (UFC) por gramo o mililitro, para indicar la potencia del producto. En este sentido, la dosificación de los probióticos biorremediadores es en función de UFC. En las Tablas 3 y 4, se muestran los resultados de dos estudios relacionados con el uso de un probiótico comercial (Mainstanq de Virbac) en presentación de tabletas, con ingrediente activo de un consorcio bacteriano conformado por las cepas B. licheniformis, B. pumilus y B. subtilis, usado como biorremediador en el fondo del estanque de cultivo. En ambos estudios se aprecia lo siguiente:
Mainstanq
Mainstanq
Mainstanq
3 La repuesta del biorremediador es dosis dependiente, a mayor número de UFC/ml, el producto muestra una significativa reducción de Vibrio spp (UFC/ml); así como de materia orgánica.
3 El producto en ambos estudios muestra que es eficaz en dosis de concentración 10¹, 10² y 10³ UFC/ ml, permitiendo ajustar la misma a las diferentes situaciones de biomasa y calidad de agua en el estanque.

Muchas especies del género Bacillus se han empleado en la medicina y la industria farmacéutica para controlar diversas enfermedades en humanos, animales y plantas, como agente de control biológico, debido a su capacidad para sintetizar una amplia variedad de metabolitos con actividad antimicrobiana.
Dosis altas, como 10³ UFC/ml, se recomiendan para sistemas de cultivo semicerrados y/o cerrados, donde la retención del agua es por periodos prolongados, tales como:
3 Camarones: tanques de larvicultura, criaderos o maternidades, y precriaderos.
3 Tilapias: incubación de huevos, tanques de reversión, precriaderos y alevinaje.
Para sistemas abiertos como estanques, para ambas actividades de cultivo, se recomiendan dosis de 10¹ y 10² UFC/ml, dependiendo de la biomasa de cultivo y materia orgánica del estanque. La aplicación de la dosis seleccionada debe efectuarse al menos dos veces por semana durante el ciclo de cultivo, a fin de mantener un nivel alto de UFC/ml.
La administración de probióticos a peces y camarones a través del agua de cría también es una práctica común que ha recibido mucha atención. Desde el punto de vista tecnológico, los probióticos desarrollados para este tipo de aplicaciones deben estar formulados con ciertas características específicas, tales como: buena estabilidad en el agua, control de la flotación en los tanques/ estanques y alta concentración que favorezca una dosis diaria baja. Se trata de productos específicamente formulados. Las estrategias de “biorremediación” están implicadas principalmente en microorganismos vivos para estanques de camarones y peces (Castex et al., 2014).
El género Bacillus ha presentado un gran potencial de uso para la biorremediación en acuicultu-

ra. Modula una amplia gama de parámetros de calidad del agua, tales como: transparencia y sólidos disueltos totales, alcalinidad, pH, conductividad, demanda química de oxígeno, oxígeno disuelto, demanda biológica de oxígeno, alcalinidad, fosfatos, especies nitrogenadas, dureza y metales pesados; así como, el mantenimiento del equilibrio microbiano y, por lo tanto, la reducción de microbios patógenos (Hlordz et al., 2020).

Este artículo es patrocinado por: VIRBAC
Las referencias y fuentes consultadas por el autor en la elaboración de este artículo están disponibles bajo petición previa a nuestra redacción.
* Mario Aguirre. Soporte técnico acuicultura. Especies de aguas cálidas. Latinoamérica. Virbac.

Evaluación científica del aditivo funcional Digextra Aqua en tilapia: mejoras comprobadas en eficiencia alimenticia, salud intestinal, calidad del agua y rentabilidad productiva.
Por: Redacción de PAM*
La acuicultura enfrenta actualmente importantes desafíos en cuanto a eficiencia alimenticia, salud intestinal de los peces y sostenibilidad productiva. En este contexto, se
validación científica de este aditivo a través de ensayos toxicológicos, microbiológicos e histológicos, así como pruebas de campo en México y Brasil. Los resultados evidencian mejoras en la conversión alimentievaluó el desempeño de Digextra Aqua, un aditivo funcional diseñado para mejorar estos aspectos críticos en la producción de tilapia. El presente reporte documenta la composición, mecanismo de acción y

Digextra Aqua mostró efectos antimicrobianos frente a varias bacterias patógenas comunes en acuicultura. También presentó una alta capacidad de adsorción de micotoxinas, reduciendo su biodisponibilidad en el tracto digestivo y mitigando su impacto negativo en el metabolismo del pez.
cia, homogeneidad de talla, salud intestinal y calidad del agua, con implicaciones económicas significativas para los productores.
Introducción
La acuicultura moderna exige soluciones funcionales que contribuyan a optimizar el factor de conversión alimenticia (FCR, por sus siglas en inglés), fomentar la salud intestinal de los peces y mejorar la sostenibilidad productiva sin recurrir a antibióticos. En este contexto, se ha desarrollado Digextra Aqua, un aditivo alimenticio innovador respaldado por más de ocho años de investigación científica aplicada y validación en campo. El presente artículo tiene como objetivo ofrecer una evaluación científica detallada de Digextra Aqua, incluyendo su composición, mecanismos de acción, estudios experimentales, impactos económicos y recomendaciones de aplicación.
Composición y mecanismo de acción
Digextra Aqua está compuesto por extractos hidrolizados de paja de trigo (Triticum aestivum) y Saccharum bengalense. Estos componentes presentan una alta concentración de polifenoles, que ejercen funciones antioxidantes e inmu-
nomoduladoras. Se ha comprobado que estos compuestos:
3 Estimulan la actividad enzimática endógena.
3 Promueven la integridad del epitelio intestinal.
3 Favorecen el desarrollo de una microbiota beneficiosa.
3 Disminuyen la vulnerabilidad del pez frente a condiciones de estrés ambiental y enfermedades.
Evidencia científica y validación de campo
Diversos estudios han sustentado la eficacia de Digextra Aqua desde una perspectiva científica. A continuación, se detallan los más relevantes:
Ensayos de toxicidad e inocuidad
Se realizaron estudios toxicológicos en peces, estableciendo una dosis segura de hasta 5,000 mg/kg sin generar efectos adversos. Esta información es crítica para su aplicación práctica en sistemas de producción intensiva, donde la seguridad alimentaria es prioritaria.
Evaluación antimicrobiana y de unión a micotoxinas
Digextra Aqua mostró efectos antimicrobianos frente a varias bacterias patógenas comunes en acuicultura, como Vibrio, Aeromonas,
algunas cepas de Streptococcus y Escherichia coli. También presentó una alta capacidad de adsorción de micotoxinas, reduciendo su biodisponibilidad en el tracto digestivo y mitigando su impacto negativo en el metabolismo del pez.
Análisis histológico intestinal
Mediante estudios histológicos realizados por la Universidad Autónoma de Baja California (UABC), se evidenció un incremento en la longitud de las vellosidades intestinales en peces alimentados con dietas suplementadas con Digextra Aqua. Esta evidencia es indicativa de una mayor superficie de absorción de nutrientes, lo cual favorece el crecimiento y la homogeneidad de talla en el lote.
Efecto sobre la calidad del agua
Se documentó una reducción significativa en la concentración de amoníaco en el agua en los sistemas tratados. Este hallazgo sugiere una mejor metabolización del nitrógeno dietético, lo cual contribuye a mantener condiciones de cultivo más estables y saludables.
Estudios de campo en tilapia: resultados detallados
Se realizaron dos estudios de campo independientes en México y otro en

Brasil para evaluar el desempeño práctico de Digextra Aqua bajo distintas condiciones de producción.
Estudio en México (2022)
1. Diseño Experimental
3 Lugar: México.
3 Especie: Oreochromis niloticus (tilapia).
3 Diseño: tres tratamientos (T1: control sin aditivo, T2: 1 kg/T, T3: 0.7 kg/T).
3 Número de peces: 600 tilapias juveniles distribuidas en 15 tanques de 1,500 L.
3 Variables evaluadas: peso final, ganancia de peso, consumo de alimento y FCR.
2. Resultados
3 El T2 (1 kg/T) mostró un incremento del 32% en ganancia de peso (127.27 g) en comparación con el grupo control (96.45 g).
3 El FCR se redujo de 1.175 (control) a 1.016 (T2), lo cual representa una mejora significativa en eficiencia alimenticia.
3. Interpretación
Estos datos evidencian que la inclusión de Digextra Aqua mejora la digestibilidad y absorción de nutrientes, resultado del efecto combinado de sus compuestos bioactivos sobre la salud intestinal y la microbiota.


Estudio en granja comercial, Brasil (2023)
1. Diseño Experimental
3 Lugar: granja comercial en São Paulo, Brasil.
3 Población: 20,000 peces.
3 Tratamientos: alimento base con y sin 1% de Digextra Aqua
3 Parámetros monitoreados: peso final, calidad del agua (amoníaco, nitritos) y tasa de supervivencia.
2. Resultados
3 Aumento del 17.25% en peso final en el grupo tratado.
3 Disminución significativa en la concentración de amoníaco (p < 0.05).
3 Reducción en el coeficiente de variación en talla, alcanzando mayor homogeneidad del lote.
3. Interpretación
El aditivo mostró eficacia bajo condiciones comerciales reales, fortaleciendo su potencial como herra-
mienta de uso continuo o estratégico en fases críticas del cultivo.
Estudio Bioworld – Unidad Acuícola“El Santuario”,Chiapas, México (2024-2025)
1. Diseño Experimental
3 Lugar: Unidad de Producción Acuícola “El Santuario”, presa Belisario Domínguez “La Angostura”, Socoltenango, Chiapas.
3 Duración: octubre 2024 – mayo 2025 (fase de preengorda de 40 días + engorda total de 200 días).
3 Especie: tilapia nilótica, genética Tapachula.
3 Número de peces: Grupo control: 211,500; Grupo tratado con Digextra Aqua: 232,677.
3 Tratamientos: dieta estándar vs. dieta con 1% Digextra Aqua (10 kg/ton).
3 Alimentación: comida comercial Top Fish con incorporación directa del aditivo desde fábrica.
2. Monitoreo y evaluación
3 Parámetros sanitarios: análisis parasitológico mensual de branquias y aletas, prevalencia, intensidad y abundancia de parásitos.
3 Parámetros de calidad del agua: temperatura y oxígeno disuelto (monitoreo diario con oxímetro YSI Pro20).
3 Variables productivas: mortalidad diaria y acumulada, recuperación (%), ganancia de peso diaria, FCR, consumo de alimento, crecimiento y clasificación por talla.
3. Resultados clave
Los resultados comparativos entre el grupo control y el alimentado con Digextra Aqua se detallan en la Tabla 1.
4. Análisis de resultados
A pesar de que el grupo tratado con Digextra Aqua inició con desventajas significativas en cantidad y peso inicial, superó al grupo de control en todos los indicadores críticos. Se observó una mejora de 58 g en el peso final promedio y una reducción del 0.33 en FCR, lo que implicó un ahorro de 8.1 toneladas de alimento. Además, la supervivencia fue 10% superior y hubo menor incidencia de enfermedades, con menor necesidad de antimicrobianos. Esto sugiere un fortalecimiento del sistema inmune y una mayor eficiencia metabólica general.
5. Impacto en la evaluación global
Este estudio refuerza de manera concluyente los beneficios del uso de Digextra Aqua en condiciones reales de cultivo. Al integrarlo con los estudios previos de México y Brasil, se consolida una evidencia robusta y coherente sobre su impacto positivo en la eficiencia productiva, salud intestinal, homogeneidad de talla, reducción de mortalidad y optimización del uso de alimento.
Discusión de resultados
Los resultados obtenidos a lo largo de los tres estudios de campo — realizados en México (2022), Brasil (2023), y México, Chiapas (20242025)— demuestran de forma contundente y consistente los beneficios del uso de Digextra Aqua en la tilapicultura latinoamericana.
Se observaron repeticiones positivas en todos los ensayos, destacando:
3 Reducción significativa del FCR entre 0.159 y 0.33 en todos los estudios, lo que representa una mejora consistente en la eficiencia alimenticia.
3 Mejora de la ganancia de peso y del crecimiento diario, incluso en poblaciones con desventajas iniciales, con incrementos de hasta 32% en ganancia de peso y +0.63 g diarios.
3 Reducción en la mortalidad y mejora en la tasa de supervivencia, reflejando beneficios inmunológicos significativos en todos los contextos de cultivo.
3 Disminución del uso de alimento (hasta 8 toneladas menos, lo que representa el 21% de ahorro en alimento) y de antimicrobianos, lo cual respalda su acción sobre la salud intestinal y estabilidad del sistema.
3 Mejor homogeneidad de talla y mayor recuperación productiva, minimizando descartes y rezagos, y favoreciendo lotes más uniformes.
3 Estos resultados se repitieron independientemente de la geografía, densidad, dieta o método de cultivo. Esta consistencia en diferentes escenarios confirma que Digextra Aqua no solo es eficaz, sino también adaptable y robusto para condiciones reales de producción comercial.
artículo
Análisis de Rentabilidad (ROI)
El uso de Digextra Aqua permite ahorrar aproximadamente 330 kg de alimento por tonelada, lo que equivale a USD 280.00 en valor de alimento. Tras descontar el costo del aditivo, se obtiene una ganancia neta de USD 227.30 por tonelada de alimento tratado.
Proyección económica por escala de productor
De acuerdo con los resultados obtenidos (en promedio en estos tres estudios), dependiendo de la escala, los beneficios se amplifican significativamente:
3 Pequeño Productor (10 T) : ahorra 3.3 toneladas de alimento, lo que equivalen a ganar USD 2,805.
3 Mediano Productor (50 T): ahorra 16.5 toneladas, representando una ganancia de USD 14,280.
3 Gran Productor (200 T): ahorra 66 toneladas, lo que supone una ganancia de USD 56,100.
3 Esto muestra un impacto económico acumulativo directo.
Peso Final
3 En todos los estudios, los peces tratados alcanzan un mayor peso final (Figura 1).
3 Incrementos de hasta 60 g adicionales por pez reflejan mejor aprovechamiento nutricional.
Ganancia Diaria de Peso
3 Se observa un aumento constante de ganancia diaria en peces tratados, con mejoras de hasta +0.6 g por día, acelerando tiempos de engorda (Figura 2).
Mortalidad
3 Digextra Aqua reduce la mortalidad en todos los ensayos, en promedio entre 6% y 10% menos (Figura 3).
3 Esto implica mayor recuperación de inversión en cada ciclo de cultivo.
Conversión alimenticia
La Figura 4 evidencia una reducción clara del FCR en todos los estudios con Digextra Aqua, mostrando mayor eficiencia alimenticia. Esto implica menor consumo de alimento por kilo producido, lo que se traduce en ahorro económico directo para el productor.

Digextra Aqua, un aditivo alimenticio innovador respaldado por más de ocho años de investigación científica aplicada y validación en campo.



Recomendaciones técnicas de aplicación
Para una aplicación eficiente, Digextra Aqua debe administrarse vía recubrimiento en frío a razón de 0.7 a 1.0 kg por tonelada de alimento. Se recomienda su uso:
3 Durante todo el ciclo de engorda.
3 En fases críticas: inicio del cultivo, cambios de temperatura y densificación.
3 En dietas extruidas, peletizadas o microencapsuladas.


Phytaxis S.A. ofrece asistencia técnica personalizada, ajustando dosis y protocolos según el sistema productivo, calidad del agua y tipo de dieta.
Conclusión y proyecciones futuras
Los resultados aquí presentados posicionan a Digextra Aqua como una herramienta integral para la tilapicultura técnica, aportando:
3 Mayor eficiencia productiva.
3 Reducción del impacto ambiental.
3 Sostenibilidad operativa.
3 Incremento de la rentabilidad.
Phytaxis S.A. continúa desarrollando versiones mejoradas del aditivo, incluyendo metabolitos de algas y bacterias ácido-lácticas, alineándose con la tendencia global hacia soluciones naturales, libres de antibióticos y adaptables a la trazabilidad y bienestar animal.
Se recomienda preferentemente la inclusión de Digextra Aqua de forma directa en la planta de fabricación del alimento para peces y camarones, con el fin de maximizar el potencial del producto y asegurar un mejor desempeño zootécnico.


En el dinámico contexto de la acuicultura, las tácticas nutricionales han experimentado una transformación radical, evolucionando desde métodos convencionales hacia sistemas inteligentes basados en datos. Eruvaka Technologies está a la vanguardia de esta transformación con su innovador sistema de alimentación asistida por hidrófono: ShrimpTalk
Por: EruvakaTechnologies*
Adiferencia de los sistemas de alimentación convencionales, ShrimpTalk, la solución de Eruvaka aprovecha el monitoreo acústico avanzado basado en inteligencia ar-
¿Por qué alimentación acústica? El alimento es un componente crítico en la cría de camarón, ya que a menudo supone entre el 60% y el 70% de los costos operativos. Los alimentadores automáticos han metificial (IA) para ofrecer un enfoque de alimentación altamente preciso, estableciendo nuevos puntos de referencia en la eficiencia de la alimentación, el crecimiento del camarón y la sostenibilidad.

ShrimpTalk minimiza el suministro innecesario de alimento, reduciendo los costos de alimentación y mitigando al mismo tiempo el impacto medioambiental de la cría de camarón.
jorado notablemente la eficacia al suministrar pequeñas cantidades de alimento a intervalos regulares, lo que garantiza un suministro continuo de alimento fresco, mejorando el crecimiento de los camarones, la calidad del agua y la uniformidad de la biomasa. Sin embargo, la decisión de cuánto y cuándo alimentarlos sigue recayendo en el acuicultor. La alimentación acústica con ShrimpTalk lleva la cría de precisión al siguiente nivel. Dado que los acuicultores no pueden observar el comportamiento de los camarones bajo el agua, los sensores acústicos “escuchan” su actividad y, mediante algoritmos inteligentes, dirigen los alimentadores automáticos para que dispensen el alimento con precisión cuando es necesario. La tecnología de alimentación acústica en la cría de camarón aprovecha los avanzados sistemas de detección de sonido para vigilar el comportamiento alimentario de los organismos y automatizar la alimentación con gran precisión. Este proceso mejora la
eficacia, optimiza el crecimiento de los camarones, reduce los residuos y mejora su salud.
¿Qué diferencia a ShrimpTalk?
Una inmersión técnica
1.Tecnología acústica avanzada basada en inteligencia artificial: la precisión en su núcleo Lo que distingue a ShrimpTalk es su inigualable precisión, impulsada por una combinación de avanzada tecnología de hidrófonos y algoritmos altamente refinados. A diferencia de muchos sistemas acústicos convencionales, ShrimpTalk está diseñado específicamente para captar los matices únicos de las marcas acústicas distintivas. Cuando los camarones consumen alimento, sus piezas bucales producen sonidos mecánicos característicos. ShrimpTalk analiza continuamente estos sonidos en tiempo real e indica a los alimentadores que suministren alimento en función de la actividad de los camarones, maximizando la eficacia de la alimen-
tación. El aprendizaje continuo de ShrimpTalk le permite ser más inteligente con el tiempo, proporcionando una alimentación más precisa a medida que aprende más acerca de cada estanque.
2.Algoritmos adaptativos de procesamiento de señales: aprendizaje y evolución
ShrimpTalk funciona con algoritmos avanzados que monitorean continuamente los sonidos de alimentación, aprendiendo de los datos históricos para perfeccionar las estrategias de alimentación. Filtra eficazmente el ruido de fondo de aireadores, otras especies de peces, pájaros, etc. Este aislamiento preciso del sonido es crucial, ya que garantiza que solo los sonidos genuinos de alimentación activen los ciclos, minimizando el desperdicio de alimento y las falsas alarmas. Mediante el análisis de las tendencias en el comportamiento de los camarones, el sistema adapta los programas de alimentación en función de diversos factores.
La tecnología de alimentación acústica de ShrimpTalk en la cría de camarón aprovecha los avanzados sistemas de detección de sonido para vigilar el comportamiento alimentario de los organismos y automatizar la alimentación con gran precisión.
Este enfoque adaptativo garantiza que la alimentación se ajuste a las necesidades específicas de los organismos, minimizando el desperdicio y maximizando el crecimiento.
3.Análisis de datos integrados: información práctica para los acuicultores
Más allá del control de la alimentación, el ecosistema de productos de Eruvaka ofrece una completa plataforma de análisis de datos que proporciona información procesable sobre el comportamiento de los camarones, los patrones de alimentación y la salud general del estanque. Los acuicultores pueden monitorear métricas clave como respuesta de alimentación, tasas de consumo de alimento y tendencias de crecimiento a través de un panel intuitivo accesible mediante aplicaciones móviles o web. Esta información permite a los acuicultores tomar decisiones con conocimiento de causa y mejorar el rendimiento general de la granja.
4.Sostenibilidad y rentabilidad: el efecto dominó
Reducir el desperdicio de alimento se traduce directamente en un ahorro de costos. ShrimpTalk minimiza el suministro innecesario de alimento, reduciendo los costos de alimentación y mitigando al mismo tiempo el impacto medioambiental de la cría de camarón. El exceso de alimento se descompone en el estanque, liberando nutrientes nocivos que pueden degradar la calidad del agua y aumentar el riesgo de enfermedades. Al dispensar alimento solo cuando los camarones se alimentan activamente, ShrimpTalk mantiene una calidad óptima del agua y mejora el fondo del estanque, promoviendo organismos más sanos y reduciendo la huella medioambiental.
Impacto en el mundo real
ShrimpTalk ya está causando sensación en más de 12 países. Los acuicultores que lo utilizan informan de las mejoras en los KPI de sus cul-
tivos, entre los que destacan crecimiento semanal, supervivencia, biomasa cosechada, factor de conversión alimenticia (FCR, por sus siglas en inglés) y costo de producción (Figura 1).
Además de estos beneficios, los acuicultores también destacan:
3 Camarones de tamaño más uniforme y más sanos.
3 Mayor calidad del agua para un crecimiento óptimo.
3 Mejores condiciones del fondo del estanque, lo que reduce el riesgo de enfermedades.
Aprovechando la IA, Eruvaka optimiza el asesoramiento alimentario y transforma la cría de camarón en una empresa responsable con el medio ambiente y basada en datos, aumentando significativamente los márgenes de ganancia por hectárea y día.



ShrimpTalk filtra eficazmente el ruido de fondo de aireadores, otras especies de peces, pájaros, etc. Este aislamiento preciso del sonido es crucial, ya que garantiza que solo los sonidos genuinos de alimentación activen los ciclos de alimentación, minimizando el desperdicio de alimento y las falsas alarmas.
Pioneros en el futuro de la cría de camarón
En una industria acuícola competitiva y en rápida evolución, la capacidad de aprovechar los conocimientos basados en datos de IA para optimizar las prácticas de alimentación puede cam-
biar las reglas del juego. Eruvaka Technologies , con su sistema de alimentación asistida por hidrófono ShrimpTalk , está estableciendo un nuevo estándar en la alimentación de precisión, ofreciendo a los acuicultores una poderosa herramienta para mejorar la rentabilidad, redu-

cir los riesgos y promover la sostenibilidad. Al combinar la IA avanzada con algoritmos adaptativos y análisis de datos, Eruvaka no se limita a alimentar camarones, sino que está transformando la acuicultura para alimentar el futuro. E

Este artículo es patrocinado por:

A menos de dos meses, la feria sigue consolidándose como el evento líder en América Latina.
Más de 140 empresas de Asia, América y Europa han asegurado su participación en esta importante exhibición que se llevará a cabo del 3 al 5 de septiembre en Lima, Perú.
Por: Comité Organizador de la “Feria Internacional Expo Pesca & Acuiperú - Seafood Lima 2025”
Este evento, reconocido por reunir a los principales actores de la industria, ofrecerá una plataforma ideal para establecer conexiones comerciales, conocer las últimas innovaciones tecnológicas y fortalecer el crecimiento del sector pesquero, acuícola y seafood en la región.
Durante tres días, más de 9,500 visitantes de Primer Nivel se darán cita en busca de las últimas tecnologías, soluciones sostenibles, maquinaria, embarcaciones, insumos, empaques, sistemas de refrigeración y automatización de la industria pesquera, acuícola y seafood
Los espacios disponibles son cada vez más limitados, esta es una oportunidad estratégica para conec-
tarte con miles de compradores profesionales de todo el mundo.
Ventajas de participar como exhibidor
3 Oportunidad de mostrar sus productos y servicios a un público especializado.
3 Generar contactos clave y nuevas oportunidades de negocio.
3 Potenciar su marca en un mercado en constante crecimiento.
3 Participar en el congreso técnico.
¿Cómo obtener su pase de visitante?
1. Escanear el QR o ingresar al Link: https://cutt.ly/DrIIYF5D.
2. Completar todos los datos solicitados en el Formulario.
3. Recibirá un correo electrónico con el Boarding Pass adjunto que debe imprimir y llevar a la Sala de Registro de la Feria para que le entreguen su Credencial de Visitante válida por los tres días del evento.
(*) El Registro Web será válido hasta las 8:00 p.m. del 02 de septiembre de 2025.
Este artículo es patrocinado por: FERIA INTERNACIONAL EXPO PESCA & ACUIPERÚ –SEAFOOD LIMA 2025
Información de contacto: Correos electrónicos: bsanchez@thaiscorp. com – gdelatorre@thaiscorp.com Whatsapp: +51 987-421-834; +51 982-508-607

Por: Antonio Garza de Yta*

Cuando vemos que de pronto una empresa o tecnología empieza a aparecer en todos lados y es la mejor forma de producir algo, más innovadora y que rompe todos los paradigmas, siempre es bueno tomar las cosas con cautela. La combinación de “influencers” y “excelsheeters” ha recaudado cientos de millones de dólares para proyectos imposibles, irreales, y que siguen pasando el sombrero a diestra y siniestra a inversionistas de todo el mundo, dañando la reputación de nuestra industria.
Mi abuelo tenía un dicho muy cierto… “mientras más ruido haga una carreta menos carga lleva”. Como en realidad nunca vi muchas carretas en mi vida, tal vez no le di la importancia necesaria a ese sabio refrán. Hoy, cuando veo lo que pasa día a día con las redes sociales y la acuicultura, aprecio más ese viejo adagio. Veo gente que lo único que hace es pasar el tiempo en redes sociales, escribiendo blogs y comentando de todo. Eso estaría bien si no lo hicieran con una misión oculta, pero desgraciadamente, por lo general, lo hacen con el afán de vendernos algo, que comúnmente no es muy sólido, ni científica ni financieramente.
Todas las empresas deben tener una etapa de promoción, en eso estoy de acuerdo. Pero, cuando vemos que de pronto una empresa o tecnología empieza a aparecer en todos lados y es la mejor forma de producir algo, de la forma más innovadora y que rompe todos los paradigmas, siempre es bueno tomar las cosas con cautela antes de precipitarnos e invertir en esa tecnolo-
gía o cambiar de tajo lo que hacemos. Últimamente la reputación de la acuicultura se ha visto muy dañada por estos proyectos mágicos, increíbles, a los cuales se les incluyen todos los adjetivos correctos de moda para marcar todas las casillas de lo políticamente correcto que las organizaciones internacionales y los financieros están buscando: ecosistemas sostenibles, resilientes, adaptables eficientemente al cambio climático, generando empleos azules, incluyentes, mejorando la calidad de vida de los implicados, etc., etc. Todo eso de verdad es necesario, lo digo de corazón, pero escucharlo todo junto, de tajo, solo quiere decir que el proyecto no tiene mucho fondo, o que el promotor es alguien que no está relacionado con el sector acuícola. Y es ahí cuando aparecen los “excelsheeters” (término que no está exactamente escrito de la misma manera por la persona que me lo enseñó, pero por motivos de mantener esta columna para todo público lo escribiré así). Esta raza de personajes financieros que tienen la capacidad mágica de reducir los tiempos de producción, bajar las
conversiones alimenticias, encontrar nichos de mercado que compren nuestro producto a un precio muy por arriba del promedio del mercado y/o producir a un costo por kilo que resultaría cuasiimposible para el más experimentado de los acuicultores, y que saben colocar todo esto en las corridas financieras de tal manera que parece que la acuicultura pueda ser más rentable que la generación de tecnología aeroespacial. Todo mundo puede ser millonario por un día haciendo corridas financieras en Excel, por eso los “excelsheeters” son tan peligrosos. La combinación de estos “influencers” y “excelsheeters” ha recaudado cientos de millones de dólares para proyectos imposibles, irreales, y que siguen pasando el sombrero a diestra y siniestra a inversionistas de todo el mundo, dañando la reputación de nuestra industria.
Muy pocas veces he visto a los verdaderos acuicultores tratar de comunicar lo que hacen y, tal vez, sería positivo para la industria que de alguna manera estos grandes emprendedores tuvieran mejores capacidades de comunicación

Así que antes de pensar en proyectos de grandeza, debemos pensar cómo vamos a pagarlos, y esto puede ser muy poco glamoroso y generar que los “influencers” no vendan publicidad, pero yo prefiero poder seguir viendo a la gente a la cara y no engañarlos con falsas expectativas. y transmitieran lo verdaderamente importante. Creo que lo primero que nos dirían para que podamos navegar en estos tiempos es que debemos mantenernos humildes y apegados a los principios básicos. No porque podamos conseguir fondos gigantescos para una operación, esta se hará más rentable. No se trata de la cantidad de dinero que podamos recaudar, sino en la cantidad de dinero que somos capaces de generar de una manera consistente para pagar lo recauda-
do. Así que antes de pensar en proyectos de grandeza, debemos pensar cómo vamos a pagarlos, y esto puede ser muy poco glamoroso y generar que los “influencers” no vendan publicidad, pero yo prefiero poder seguir viendo a la gente a la cara y no engañarlos con falsas expectativas. Así que seamos realistas, pragmáticos y modestos, y sobre todo, recordemos que esto no es una carrera de cien metros, sino un maratón, y aún nos faltan muchos kilómetros para llegar a la meta.
* Antonio Garza de Yta es COO de Blue Aqua International-Gulf, vicepresidente del Centro Internacional de Estudios Estratégicos para la Acuacultura (CIDEEA), presidente de Acuacultura sin Fronteras (AwF), expresidente de la Sociedad Mundial de Acuacultura (WAS), exsecretario de Pesca y Acuacultura de Tamaulipas (México) y creador de la Certificación para Profesionales en Acuacultura (CAP) junto con la Universidad de Auburn.

Por Stephen Newman, Ph.D.*

¿Pueden
El término “probiótico” se aplica a las bacterias para una amplia gama de propósitos, normalmente sin una consideración adecuada de lo que los estudios científicos rigurosos demuestran en realidad sobre los efectos y beneficios específicos de esos microbios. Soy de la opinión de que los supuestos mecanismos de acción de este término de uso común, en su aplicación a la cría de camarones, son inexactos para la mayoría de los productos comerciales.
La mayoría de la gente, cuando oye o emplea el término probiótico, piensa en un yogur con muchas especies microbianas diferentes añadidas.
Estos “probióticos” se consumen por vía oral y las bacterias que sobreviven a la barrera de un estómago ácido (que no es la norma en camarones, ya que tienen un intestino
con un pH casi neutro) se desplazan por el tracto digestivo, donde colonizan alguna parte del intestino. Se afirma que esto altera el microbioma existente y las bacterias

Existen mecanismos por medio de los cuales los probióticos podrían, en teoría, curar o prevenir enfermedades. Entre ellos se incluye la competencia por nutrientes esenciales, como cofactores enzimáticos (metales como el Fe o vitaminas) o producción de antibióticos o péptidos antimicrobianos que inhibirán cepas específicas.
añadidas se convierten en un componente estable del microbioma. Se supone que esto repercute positivamente en la salud del receptor.
Esta definición tan específica omite la gran cantidad de otras repercusiones que pueden tener las bacterias, desde el impacto en el medio ambiente a través de la biorremediación hasta la estimulación de la inmunidad no específica en el receptor, etc. También es polémica. El microbioma es un conjunto complejo de múltiples especies de bacterias, hongos y protozoos que colonizan superficies externas e internas. Muchas de las pruebas existentes hasta la fecha sugieren que la adición de “probióticos” puede (o no) causar alteraciones a corto plazo en el microbioma, en el mejor de los casos. La aparente necesidad de dosificar continuamente los probióticos sugiere de manera clara que cualquier alteración del microbioma es temporal.
Muchas bacterias degradan la materia orgánica. Muchas también convierten el amoníaco en metabolitos como nitrito, nitratos y nitrógeno atmosférico. Pueden tener
rangos de actividad estrechos u otros rasgos que las hagan poco adecuadas para su uso en productos comerciales para la acuicultura. Algunas son muy buenas, mientras que otras pueden ser extremadamente fastidiosas y otras son poco adecuadas. Algunas empresas ofrecen cepas de Nitrobacter y Nitrosomonas para la nitrificación. Muchas otras bacterias también lo hacen, incluidas varias especies de Bacillus, que pueden secarse, tienen una forma de espora estable en estantería, no requieren refrigeración y no son muy caras. Muchas empresas venden mezclas de bacterias que compiten entre sí, lo que puede reducir la eficacia global del proceso. La variabilidad inherente a los entornos de producción exige que cualquier enfoque estandarizado tenga en cuenta estas variables. Las paredes celulares de muchos microbios diferentes son capaces de estimular el sistema inmunitario. Esto está bien documentado tanto para peces como para camarones (y mamíferos). En el caso de camarones, el impacto es en gran medida no-específico, ya que no forman
anticuerpos, un componente de la respuesta humoral clásica. La naturaleza y la intensidad del impacto dependen de una serie de variables, entre ellas, cantidad de material al que están expuestos, forma, frecuencia de exposición, nivel de estrés de los organismos y funcionamiento de su sistema inmune. Estos factores determinan la intensidad de la reacción inmunitaria.
Muchos estudios de laboratorio se basan en la exposición de organismos en condiciones controladas que no se corresponden con el mundo real. Pueden estar en acuarios o microcosmos con un intercambio de agua limitado, lo que garantiza que ingieran los compuestos repetidamente y a través de múltiples vías. Además, en el caso de las especies de Bacillus formadoras de esporas que germinan y crecen en estos sistemas a niveles suficientemente altos, las células vegetativas son las responsables del impacto observado, no las esporas. Las esporas germinan a velocidades que dependen del entorno y de la cepa. Los patógenos se dividen en dos categorías generales. Son obligados

u oportunistas. Muchas bacterias aisladas de organismos enfermos no son la causa de la enfermedad, sino que se aprovechan de su sistema inmunitario debilitado, son oportunistas. Los patógenos obligados pueden causar enfermedades en organismos fuertes y sanos solo con su mera presencia en determinados niveles, proliferar y causar la enfermedad. Los patógenos muy virulentos poseen determinantes de virulencia, propiedades que garantizan que puedan dañar a los organismos sanos. Algunos ejemplos serían las toxinas (como las toxinas
PirA y PirB en las cepas de Vibrio parahaemolyticus), enzimas potentes que están presentes en niveles lo suficientemente altos como para dañar los tejidos y con capacidad para secuestrar nutrientes críticos como el hierro (los vibriones pueden contener genes que codifican para que las proteínas de la membrana externa se unan a estos, haciendo que no estén disponibles para el hospedador), etc.
La mayoría de las veces, las enfermedades agudas de los camarones de piscifactoría son el resultado de múltiples patógenos. Puede
tratarse de una mezcla de patógenos oportunistas o de patógenos obligados y oportunistas. En los camarones de piscifactoría, la infección por patógenos como el virus que causa la mancha blanca (WSSV, por sus siglas en inglés) o el agente etiológico fúngico responsable del Enterocytozoon hepatopenaei (EHP) suelen ir acompañados de bacteriemias, de las que los vibrios suelen ser un componente principal. Hay muchas otras especies de bacterias que pueden ser problemáticas. La mayoría son oportunistas, pero unas pocas son obligadas.
Impulsar los paradigmas de producción para maximizar la productividad muy a menudo tiene como consecuencia el estrés de los organismos. Con demasiada frecuencia, los acuicultores se centran en lo que consideran el balance final: ¿Cuántas toneladas de producto final vendible se pueden producir en un estanque determinado? .

Puede haber una sinergia entre múltiples patógenos potenciales. El síndrome de las heces blancas en lso camarones (un problema común en el sudeste asiático) se debe al hongo EHP y a un vibrio juntos. El EHP por sí solo no causa mortalidad, pero cuando hay coinfección con un vibrio, el resultado son heces blancas y mortalidad aguda. A medida que aumentan los niveles de patógenos en un organismo, este puede conservar su apetito, pero no crecerá, lo que crea una disparidad significativa en los tamaños de la población en la cosecha y altos factores de conversión alimenticia. Su impacto en el hepatopáncreas, órgano crítico para la digestión y la inmunidad, debilita al camarón, haciéndolo muy susceptible a la invasión de patógenos tanto oportunistas como obligados.
Para que los probióticos sean activos mediante la alteración del microbioma y, por tanto, del metaboloma (suma de los metabolitos que produce el microbioma) en la prevención o curación de enfermedades, es necesario considerar varios aspectos. Si previenen enfermedades, tendrían que mantener las cargas de patógenos potenciales por debajo de los niveles umbral que causan enfermedades agudas. Esto, más que probablemente, requeriría que estuvieran presentes de manera constante. La mayoría de las bacterias producen péptidos antimicrobianos y otros compuestos que les permiten competir por los nutrientes a la vez que inhiben a sus competidores.
Existen mecanismos a través de los cuales los probióticos podrían, en teoría, curar o prevenir enfermedades. Entre ellos, competir por nutrientes esenciales, como los cofactores enzimáticos (metales como el Fe o vitaminas) o la producción de antibióticos o péptidos antimicrobianos (AMP, por sus siglas en inglés) que inhibirán cepas específicas. Sin embargo, requieren que una cantidad adecuada de probióticos esté lo suficientemente cerca de los patógenos para ser eficaces. Dado que ningún probiótico comercial persiste en los organismos o en el entorno inmediato a niveles elevados, es poco probable que un probiótico cure o prevenga enfermedades causadas por patógenos obligados mediante la alteración del microbioma.
Estos productos microbianos, como los AMP, no actúan de la misma manera que los antibióticos. Los antibióticos se administran a los organismos en dosis que garantizan niveles tisulares suficientemente altos para inhibir los organismos a los que van dirigidos. No actúan sobre los virus, solo sobre las bacterias y los hongos. Están localizados y los niveles generales en los tejidos no van a funcionar como lo hacen los antibióticos. La observación de que determinadas cepas de bacterias inhiben el crecimiento de otras bacterias por proximidad no significa que esto sea lo que ocurre en el hospedador. Los patógenos suelen estar en biopelículas que los protegen y aíslan, y las cargas tisulares globales son demasiado bajas para actuar como los antibióticos.
El papel del estrés en la susceptibilidad a las enfermedades está bien documentado. Los factores de estrés debilitan a los organismos y los hacen menos capaces de combatir las infecciones. Estos factores incluyen, entre otros, una nutrición inadecuada (exceso o escasez de nutrientes esenciales), densidades excesivamente altas, problemas de calidad del agua (cambios repentinos de salinidad, pH demasiado bajo o demasiado alto, etc.), niveles bajos de oxígeno, niveles altos de metabolitos (H2S, CH4, nitrato, nitrito, NH3/4, etc.), presencia de cepas tóxicas de algas y bacterias, niveles bajos crónicos de patógenos, manipulación frecuente de camarones como resultado de cosechas parciales o traslados, etc.
Los organismos sanos sin estrés están en homeostasis con su entorno. Son capaces de adaptarse a perturbaciones ambientales moderadas sin impactos negativos. Los factores estresantes afectan su capacidad de adaptación y aumentan su susceptibilidad a patógenos obligados y oportunistas.
No hay soluciones mágicas. Los principios básicos influyen en los resultados. No mantener los patógenos obligados fuera de los sistemas de producción aumenta las posibilidades de que los organismos enfermen. El control empieza por los reproductores.
El control de patógenos en los camarones de una población no funciona a menos que se trabaje con organismos que hayan sido criado en interiores en condiciones controladas durante al menos varias generaciones y las pruebas repetidas no hayan encontrado nada preocupante. Debe analizarse cada organismo de forma individual. Si bien es posible que niveles bajos de patógenos obligados logren sobrevivir, no es probable que causen problemas en un entorno relativamente libre de estrés en condiciones óptimas. En aras de la precisión, hay patógenos potenciales que deben excluirse por todos los medios, ya que pueden infectar y matar a los organismos cuando están presentes en niveles muy bajos. Por fortuna, son muy poco frecuentes.
El muestreo de la población debe realizarse en nauplios, zoea, mysis y camarones postlarvarios. Las muestras deben ser representa-
Analizar camarones sanos y observar diferencias entre ellos y los enfermos no significa que los microbiomas de los organismos sanos sean responsables de su salud.
tivas de la población. Puede ser útil seleccionar camarones manifiestamente enfermos para las pruebas. Los alimentos vivos deben proceder de fuentes totalmente bioseguras y también deben someterse a pruebas exhaustivas. Con demasiada frecuencia, los criaderos usan fuentes locales de poliquetos silvestres o artemias que se producen en masa en condiciones no asépticas, lo que contamina reproductores y, luego, nauplios, zoea, mysis y camarones postlarvarios. Si las pruebas revelan un fallo de bioseguridad, el productor debe comunicar los riesgos a la clientela o destruir el lote y empezar de nuevo con organismos limpios. El entorno de producción influye en el riesgo. Si los vecinos están muy próximos y no hay salvaguardias que garanticen que no se mezclan afluentes y aguas residuales, aumenta el riesgo de introducir una enfermedad en una población sin inmunidad previa. Muchos han abordado este riesgo mediante el uso generalizado de desinfectantes, normalmente cloro, para tratar el
agua entrante antes de la fertilización y la repoblación. Como ya se dijo en un artículo anterior, esto puede empeorar las cosas.
Impulsar los paradigmas de producción para maximizar la productividad muy a menudo tiene como consecuencia el estrés de los camarones. Con demasiada frecuencia, los acuicultores se centran en lo que consideran el balance final: ¿Cuántas toneladas de producto final vendible se pueden producir en un estanque determinado? Lo ideal sería que los productores encontraran el equilibrio entre la búsqueda de la mayor producción posible y la limitación del estrés, que invariablemente es un componente de este planteamiento. Una bioseguridad adecuada y la reducción del estrés son elementos esenciales para un éxito constante.
La desinformación generalizada no ayuda al sector. Incita a la gente a pensar que no debe prestar atención a los aspectos básicos. Al final, puede garantizar que persistan los ciclos de enfermedades graves que
limitan los beneficios y se generen nuevos patógenos. Utilizar todos los medios posibles, por excesivos o inapropiados que sean, para abordar la situación (los estanques) no es la mejor manera de hacerlo. Cualquiera con amplia experiencia en la cría de camarones y peces puede dar fe de ello.
Hacer pruebas con organismos sanos y observar diferencias entre ellos y los enfermos no significa que los microbiomas de los camarones sanos sean los responsables de su salud. Incluso cuando se desafían en condiciones controladas, es más que probable que las diferencias observadas se deban a una respuesta inmunitaria no-específica. En última instancia, hay que centrarse en los fundamentos de la bioseguridad y la reducción del estrés. Una vez que se hayan abordado de forma adecuada, los beneficios serán evidentes: mayor supervivencia, mejor crecimiento, mejores índices de conversión y, en definitiva, mayores beneficios.
* Stephen G. Newman es licenciado en Conservación y Gestión de Recursos (ecología) por la Universidad de Maryland y doctor en Microbiología Marina por la Universidad de Miami. Tiene más de 40 años de experiencia trabajando en diversos temas y enfoques de la acuicultura, como la calidad del agua, la sanidad animal y la bioseguridad, con especial atención al camarón y los salmónidos. Fundó Aquaintech Inc. en 1996 y sigue siendo su director general. Se centra en la prestación de servicios de consultoría sobre tecnologías microbianas y bioseguridad en todo el mundo. sgnewm@aqua-in-tech.com www.aqua-in-tech.com www.bioremediationaquaculture.com


Organizadores:
Organizadores Locales:










ALIMENTOS BALANCEADOS
MEGASUPPLY 27 y 31
Centroamérica, EE.UU., Europa, Sudamérica, Asia y Medio Oriente
Tel: +1 305 381 0210
E-mail: orders@megasupply.net W: www.megasupply.net
NATIONAL RENDERERS
ASSOCIATION, INC…................ CONTRAPORTADA Oficina para Latinoamérica: Sierra Candela 111 Oficina 501. Lomas de Chapultepec C.P. 11000 CDMX
Contacto: Luz María Cano
Tel: (55) 55 5980 6080
E-mail: nramex@nralatinamerica.org
ZEIGLER BROS, INC.................................................1 400 Gardners, Station RD, Gardners, PA. 17324, EE.UU. Contacto: Susan Thompson
Tel: 717 677 6181
E-mail: sales@zeiglerfeed.com www.zeiglerfeed.com
ANTIBIÓTICOS, PROBIÓTICOS Y ADITIVOS PARA ALIMENTOS
BAF BIOAQUAFLOC 23
Tel: +34 613 87 18 60 W: www.bioaquafloc.com
MEGASUPPLY 27 y 31
Centroamérica, EE.UU., Europa, Sudamérica, Asia y Medio Oriente
Tel: +1 305 381 0210
E-mail: orders@megasupply.net W: www.megasupply.net
PRILABSA INTERNATIONAL CORP 13 2970 W. 84 St. Bay #1, Hialeah, FL. 33018, EE.UU.
Contacto: Roberto Ribas. Tel: 305 822 8201, 305 822 8211
E-mail: rribas@prilabsa.com www.prilabsa.com
EQUIPOS DE AIREACIÓN, BOMBEO, FILTROS, MOBILIARIO PARA LABORATORIO E INSTRUMENTOS DE MEDICIÓN
SUN ASIA AERATION INT´L Co., Ltd......................9 15f, 7, Ssu-wei 4 road, Ling-ya District, Kaohsiung, 82047 Táiwan R.O.C.
Contacto: Ema Ma.
Tel: 886 7537 0017, 886 7537 0016
E-mail: sales@pioneer.tw.com www.pioneer-tw.com
EVENTOS Y EXPOSICIONES
11VA. FERIA INTERNACIONAL DE EQUIPOS Y SERVICIOS PARA PESCA & ACUICULTURA (EXPOPESCA - ACUIPERÚ)/3RA. FERIA INTERNACIONAL DE PESCADOS, MARISCOS & DERIVADOS (SEAFOOD LIMA) 71
Sept. 3-5, 2025
Lima, Perú
T: +51 989-177-352
E: thais@thaiscorp.com
W: www.thaiscorp.com/expopesca
AQUAEXPO
INTERNATIONAL 2025........SEGUNDA DE FORROS
Oct. 20-23, 2025
Centro de Convenciones. Guayaquil, Ecuador. T: +593 99 377 1572
E: aquaexpoec@cna-ecuador.com
W: https://www.aquaexpo.com.ec/
LACQUA 2025 ......79
Oct. 6-9, 2025
Hotel Enjoy, Puerto Varas, Chile
E: carolina@was.org
W: www.was.org.
SIMCAA 2025
XV SIMPOSIO CENTROAMERICANO DE ACUICULTURA....................TERCERA DE FORROS
Ago. 19-22, 2025
Choluteca, Honduras
T: +504 9985-0819 / +504 9503-1976 / +504 2782-3301
E: jamador@andah.hn, lmaradiaga@andah.hn
W: www.andah.hn www.simcaa.com facebook.com/AndahHonduras
Panorama Acuícola Magazine
Empresarios No. #135 Int. Piso 7 Oficina 723
Col. Puerta de Hierro, C.P.45116. Zapopan, Jal. México. Cruza con las calles Av. Paseo Royal Country y Blvrd. Puerta de Hierro
Tels: +52 (33) 8000 0578
Contacto 1: Suscripciones
E-mail: suscripciones@panoramaacuicola.com
Tel: +52 (33) 8000 0629 y (33) 8000 0653
Contacto 2: Juan Carlos Elizalde, ventas y mercadotecnia
E-mail: crm@dpinternationalinc.com www.panoramaacuicola.com

Aquaculture Magazine
Design Publications International Inc.
203 S. St. Mary’s St. Ste. 160
San Antonio, TX 78205, EE.UU.
Oficina en EE.UU: +(210) 229 9036
Oficina en EE.UU, Directo: +(210) 504 3642
Oficina en México: (+52) (33) 3632 2355
Suscripciones: iwantasubscription@dpinternationalinc.com
Publicidad: crm@dpinternationalinc.com / sse@dpinternationalinc.com www.aquaculturemag.com
AQUAEXPO EL ORO 2025
Julio 20-23, 2025
Machala, Ecuador
T: +593 99 377 1572
E: aquaexpoec@cna-ecuador.com
W: https://www.aquaexpo.com.ec/
AQUA NOR
Ago. 19-21, 2025
Trondhein, Noruega
T: +47 73 56 86 40
E: post@nor-fishing.no
W: https://www.aquanor.no/en/
XV SIMPOSIO CENTROAMERICANO DE ACUICULTURA
Ago. 19-22, 2025
Choluteca, Honduras
T: +504 9985-0819 / +504 9503-1976 / +504 2782-3301
E: jamador@andah.hn, lmaradiaga@andah.hn
W: www.andah.hn
JAPAN INTERNATIONAL SEAFOOD & TECHNOLOGY EXPO
Ago. 20-22, 2025
Tokio, Japón
T: +81-3-5775-2855
E: sf@exhibitiontech.com
W: https://seafoodshow-japan.com/
GLOBAL SHRIMP FORUM
Sept. 2-4, 2025
Utrecht, Países Bajos
W: www.shrimp-forum.com
INTERNATIONAL AQUACULTURE
INNOVATION CONFERENCE, INNAQUA 2025
Sept. 2-4, 2025
Puerto Montt y Puerto Varas, Chile
T: 56 9 6617 2308
E: innaqua@clubinnovacionacuicola.cl
W: https://www.innaqua.cl/.
INTERNATIONAL FISH CONGRESS & III FISH EXPO BRASIL
Sept. 2-4, 2025
Foz do Iguaçu, Brasil
T: +55 (49) 9 8845 4767
E: panty@ifcbrasil.com.br
W: https://ifcbrasil.com.br/
11va. FERIA INTERNACIONAL DE EQUIPOS Y SERVICIOS PARA PESCA & ACUICULTURA/3era. FERIA INTERNACIONAL DE PESCADOS, MARISCOS & DERIVADOS
Sept. 3-5, 2025
Lima, Perú
W: +51 989 177 352
E: thais@thaiscorp.com
W: www.thaiscorp.com/expopesca/
VICTAM LATAM
Sept. 16-18, 2025
Sao Paulo, Brasil
T: +31 33 246 4404
E: expo@victam.com
W: https://www.allaquaculture.com/events/victamlatam-2025/
FALL CONFERENCE AT HUNTER MOUNTAIN RESORT
Sept. 16-18, 2025
New York, EE. UU.
T: (304) 802-4901
E: ustroutfarmersassociation@gmail.com
W: https://ustfa.org/2025/04/16/ustfa-announces-
2025-fall-conference-at-hunter-mountain-resort-innew-york-september-16-18-2/
AQUACULTURE EUROPE 2025
Sept. 22-25, 2025
Valencia, España
T: (+1) 760 751 5005
Fax: (+1) 760 751 5003
E: worldaqua@was.org
W: www.was.org, www.aquaeas.org
ENCUENTRO TILAPIA MÉXICO 2025
Sept. 24-25, 2025
Guadalajara, México
T: (55) 5563 4600
E: ana.garces@conafab.org
W: https://eventos.conafab.org/encuentrotilapia/ 24va. RESPONSIBLE SEAFOOD SUMMIT
Sept. 29, 2025
Cartagena, Colombia
W: https://events.globalseafood.org/responsibleseafood-summit
LAQUA 2025
Oct. 6-9, 2025
Puerto Varas, Chile
T: (+1) 760 751 5005
Fax: (+1) 760 751 5003
E: worldaqua@was.org
W: www.was.org
SHRIMP MASTERCLASS 2025
Oct. 13-15, 2025
Miami, EE. UU.
T: +1 754 268 2951
E: info@shrimpmasterclass.com
W: www.shrimpmasterclass.com
AQUAEXPO GUAYAQUIL 2025
Oct. 20-23, 2025
Guayaquil, Ecuador
T: +593 99 377 1572
E: aquaexpoec@cna-ecuador.com
W: https://www.aquaexpo.com.ec/
BUSAN INTERNATIONAL SEAFOOD & FISHERIES EXPO 2025 (BISFE 2025)
Nov. 5-7, 2025
Busan Metropolitan City, Corea
T: +82-51-740-7518,7519
E: bisfe@bexco.co.kr
W: https://bisfe.com/eng/sub01/sub01.php
WORLD AQUACULTURE 2025
Nov. 10-13, 2025
Hyderabad, India
T: (+1) 760 751 5005
Fax: (+1) 760 751 5003
E: worldaqua@was.org
W: https://was.org/Meeting/code/WAI2025
INTERNATIONAL CONFERENCE ON FISHERIES AND AQUACULTURE (ICFA)
Nov. 11-12, 2025
George Town, Malasia
T: +91 8280047516 (Call 9.00AM to 7.00PM)
E: papers.asar@gmail.com
W: https://asar.org.in/Conference/53624/ICFA/
XXI FEIRA NACIONAL DO CAMARÃO
Nov. 11-14, 2025
Natal, Brasil
T: +55 84 3231.6291
E: fenacam@fenacam.com.br
W: https://www.fenacam.com.br/



Por: Antonio Garza de Yta
Conocí a Humberto Villarreal hace 24 años, cuando yo era un recién graduado de la maestría en Acuacultura por la Universidad de Auburn y él era ya un científico consolidado en el Centro de Investigaciones Biológicas del Noroeste (CIBNOR). Desde esa fecha, nuestras vidas se entrelazaron no solo de manera profesional, sino que tuve la fortuna de hacer una amistad entrañable con uno de los seres humanos más maravillosos que haya tenido el placer de conocer.
Para los que lo conocieron de joven, su liderazgo e ímpetu se hicieron notar desde un principio. Desde su paso por el Instituto Tecnológico y de Estudios Superiores de Monterrey (ITESM), Campus Guaymas, hasta la obtención del Doctorado en Zoología por la Universidad de Queensland en Brisbane, Australia, no hubo ni un momento en el que Humberto no hubiera destacado, pero, sobre todo, trabajado en equipo y motivado a todos aquellos que lo rodeaban.
A su regreso de Australia en 1987 se integró al CIBNOR, institución a la que contribuiría a transformar en

una de las más importantes del continente en temas acuícolas. Ahí, primero fue jefe de Biología Marina de 1993 a 1995 en la Unidad Guaymas y, posteriormente, coordinador del Programa de Acuacultura en dos periodos distintos, de 1998 a 2004 y, luego, de 2007 a 2009, en La Paz, Baja California Sur, México. Durante sus casi 40 años de trayectoria publicó más de 100 artículos científicos, cuatro libros y dos capítulos de libros. Participó como editor de tres
libros e impartió más de 200 conferencias internacionales. Nuestro amigo fue un gran científico, pero aún mucho mejor maestro. Coordinó 45 tesis profesionales, y transformó la vida de por lo menos un centenar de estudiantes y profesionales que vieron a Humberto como un gran ejemplo a seguir. Sus alumnos hoy ocupan cargos destacados en la industria, el sector público y la academia, y transmiten sus enseñanzas por todo el mundo.

Humberto no solo era un hombre brillante, sino de grandes cualidades, como la de poder convencer a todos los que lo rodeábamos de cualquier cosa que quisiera. Una de las cualidades que más le admiro es la capacidad de poder hacer un “elevator pitch” y explicar los temas más complicados en 30 segundos, pero principalmente la de soñar en grande. Humberto nunca comprometió sus sueños, al contrario, luchó incansablemente para alcanzarlos. Prueba de ello fue que logró la creación del Parque de Innovación Tecnológica, BioHelis, en 2009, del cual fue coordinador hasta su deceso, y que es sin lugar a duda uno de los mejores proyectos para el desarrollo de la acuicultura que he visto a escala global, donde decenas de empresas, muchas de hoy en plena expansión, se beneficiaron.
Humberto siempre buscaba la forma de mejorar las cosas, y esa gran cualidad le acompañó toda la vida, realizando importantes trabajos en optimización de la producción y alimentación, tanto para el langostino australiano (Cherax quadricarinatus) como para el camarón blanco del Pacífico (Litopenaeus vannamei). Siempre tuvo la visión de integrar la ciencia con la indus-
tria. Un promotor de la buena gobernanza, de la participación de todos los actores para la toma de decisiones. Coordinó el Plan Rector de la Acuacultura en México en el 2008, y no me cabe duda de que, si se hubieran seguido sus recomendaciones, México ocuparía un lugar mucho más relevante en la acuicultura global.
En la Sociedad Mundial de Acuacultura (WAS, por sus siglas en inglés) fue editor del Journal (JWAS), director de la Mesa Directiva y, finalmente, presidente. Tuve el honor de compartir esta etapa con él, siempre luchando por incrementar los servicios a los miembros, la internacionalización de la sociedad y, sobre todo,


siempre abogando para incluir a los estudiantes en todas las actividades de la WAS. Su calidez y buen trato lo convirtieron de inmediato en uno de los presidentes más carismáticos que la Sociedad haya tenido en su historia. Compartimos siempre que la riqueza más grande que la WAS tiene es su diversidad, lo que la hace única e irrepetible. Su visión quedará marcada permanentemente en los anales de nuestra amada Sociedad.
Recuerdo con mucho cariño que en el evento de Montepellier de la WAS, Humberto me prestó su teléfono a las 3 de la mañana para que yo pudiera conectarme con mi familia y saber el sexo de mi hijo Patricio, a quién por la gran afición de mi esposa y la mía a la Guerra de las Galaxias, el tío Humberto, siempre llamó Darth.
Pero nosotros no coincidimos únicamente en la WAS, sino en innumerables proyectos, algunos que se convirtieron en realidad y otros que quedaron como grandes ideas. Nuestra última colaboración fue en el Advisory Board of Shrimp. Ahí, y en cualquier lugar donde nuestro amigo participó, dejó huella; su visión y legado serán irremplazables. No solamente fue un gran científico y un gran amigo, sino también un gran padre, un hombre de familia. Le sobreviven su esposa Berenice y sus dos hijas, a ellas nuestro más sentido pésame, lo único que esperamos es que la paz les llegue pronto.
Como comentó nuestro amigo Craig Browdy, siempre recordaremos la sonrisa de Humberto, las deliciosas cenas, pero principalmente su espíritu indomable. Humberto es


una de esas personas irrepetibles, que llegaron a este mundo para hacerlo un mejor lugar.
La última vez que lo vi fue cuando ambos cambiamos trenes en Dinamarca, después de una de nuestras larguísimas cenas, en donde arreglamos y desarreglamos el mundo por lo menos un par de veces. Los dos sabíamos que tal vez no volveríamos a vernos, nos dimos un abrazo y tuve la fortuna de poderle decir “te quiero mi hermano”.
Hoy, creo que toda la comunidad acuícola del planeta se une a ese momento. Humberto, mi amigo, mi hermano, mi compañero de mil batallas, donde quiera que estés, estoy seguro de que estás generando una revolución para bien, creando, soñando, compartiendo ese dejo de locura que solo los grandes como tú manejan con grandeza. No basta decir gracias, sino confirmarte, que te querremos y recordaremos por siempre.



